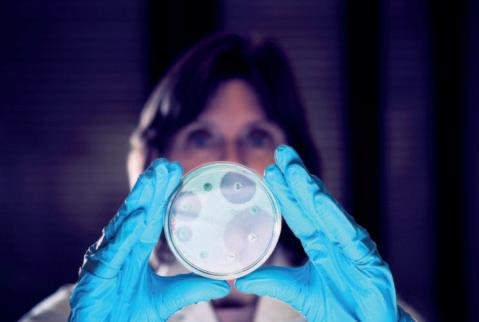

CONGRESOS
La VIII edición presentó propuestas innovadoras para la industria de alimentos
Por qué la industria alimentaria debe tomarse en serio la sostenibilidad
Stefaan Kennis - Director de Estrategia, Inteligencia de Mercado y Sostenibilidad de TOMRA Food
La carrera de Ingeniería de Alimentos se inició en 1977
Una mirada integral a los sistemas alimentarios 15 al 18 de noviembre de 2022 en Medellin, Colombia

La marca ferial que se propuso recorrer el país llega al corazón de la Argentina
Desde Córdoba a todo el país
Demanda global de maquinaria para alimen tos: foco en la economía circular, la gestión de recursos, las tecnologías digitales y la seguridad de los productos
Cumple cien años ofreciendo al mercado argentino colorante caramelo líquido y caramelo líquido de máxima calidad
Líneas de sanitizantes para frutas, verduras y hortalizas
Ofrece una amplia gama de opciones ante el desafío de los alimentos funcionales
La ingesta de fibras de raíz de achicoria aumenta las bifidobacterias y favorece la fun ción intestinal
Premezclas: una herramienta clave para la practicidad
Impacto
Organización para la Alimentación y la Agricultura de

La marca ferial que se propuso recorrer el país llega al corazón de la Argentina
Durante la exitosa realización de FITHEP en junio pasado en Buenos Aires fue relanzada la primera edición de FITHEP Expoalimentaria Centro, que tendrá lugar del 5 al 7 de junio de 2023 en la ciudad de Córdoba, Argentina.

Como exposición de tecnologías, ingredientes e insumos para el sector alimentario, la oferta de productos innovadores para la elaboración de alimentos dulces y de gastronomía es su aporte distintivo, reconocido por el mercado.
En el pasado mes de junio se realizó en el Centro Costa Salguero de Buenos Aires la 21ª edición de FITHEP Expoalimentaria Latam. Fue una edición his tórica porque, luego de tres años de postergación por la pandemia, marcó el récord de visitantes profe sionales. Más de 19.000 compradores provenientes
de toda la Argentina y países de la región se dieron cita en la reconocida feria de tecnologías y materias primas. Industriales panaderos, pasteleros, helade ros, chocolateros, pizzeros, empanaderos, alfajore ros, responsables de restaurantes y todo el segmento de la gastronomía fueron al encuentro de la innova ción, de las soluciones tecnológicas y de las nuevas tendencias que surgieron a partir de las exigencias derivadas de la pandemia. No faltaron las grandes figuras mediáticas de la gastronomía como Osvaldo Gross, Narda Lepes, Juan Manuel Herrera, Andrea González y tantos otros que interactuaron con el público profesional mientras desarrollaban elabora ciones con recetas novedosas y usando tecnologías de reciente lanzamiento.
FITHEP Latam fue la recuperación de un tiempo per dido y la inyección de entusiasmo por las nuevas opor tunidades que se abren hoy en los negocios de la gas tronomía. Los campeonatos y certámenes que se pre sentaron superaron las expectativas de los visitantes. Por primera vez tuvieron lugar tres desafíos: el Campeonato Nacional del Pan Dulce, en tres modalida
des (Genovés, Milanés y de Innovación), dirigido por el Maestro Panadero Vicente Campana. El Campeonato Nacional de la Medialuna en dos modalidades (de man teca y salada), dirigido por la Maestra Pastelera Andrea González. Y el Campeonato Nacional de Escultura en Chocolate, con el apoyo de la Federación de Pasteleros y el patrocinio de la empresa Lodiser, líder nacional en el suministro de este noble producto.

FITHEP Latam es sede de semifinales para com petir en los más prestigiosos campeonatos del mundo. En junio tuvieron lugar el Campeonato Nacional y el Latinoamericano del Helado Artesanal, a cargo de AFADHYA, y los Campeonatos Nacionales de Pastelería a cargo de la Cámara de Confiterías de la República Argentina. En todos ellos estuvo presen te el apoyo logístico y técnico de la Federación de Pasteleros. De FITHEP salieron los equipos argenti nos para competir en Rímini, Lyon y Parma.


FITHEP es una marca ferial que se propuso reco rrer el país y así lo demostró con las realizaciones de FITHEP Nordeste, FITHEP Noroeste y FITHEP Patagonia. En cada punto estratégico en donde abrió sus puertas movilizó a compradores profesio nales que interpretaron esa presencia como la voluntad de las empresas proveedoras por acercarse hasta sus clientes más distantes de la metrópoli por teña. Cabalgando en el mismo concepto, la próxima realización en Córdoba tendrá sin embargo un desafío mayor. FITHEP Centro se ofrece y promociona como una plataforma nacional de negocios. Para ello la organizadora, Publitec Editora, ha ampliado el radio de envío de invitaciones a profesionales de todo el país e inclusive a potenciales visitantes de Chile, Paraguay, Bolivia, Brasil y Uruguay.


Del 5 al 7 de junio de 2023, Publitec realizará en la Ciudad de Córdoba la primera edición de FITHEP Centro Expoalimentaria. La feria de equipamientos, tecnologías, materias primas y servicios para el sector dulce y gastronómico ha puesto ya las bases sólidas para una oferta de insumos enfocada en la innovación y con una convocatoria de compradores provenientes de todo el país.
Córdoba es una provincia que camina con sus propios pies. Varios aspectos con vergen para que este territo rio cuente con recursos que lo colocan en una situación
de privilegio. Ubicada estratégicamente en el centro del país, presenta una economía diversificada, en donde encontramos productos primarios como los provenientes de la agricultura -soja, maní, trigo, maízy de la producción animal, como carnes, lácteos y miel. Además, ha desarrollado una política industrial cuyo ícono es la producción de automóviles y auto partes, pero también de maquinaria agrícola. Toda esta actividad está asociada a la incorporación de conocimientos técnicos y tecnológicos y por eso su sector académico universitario es un fuerte respaldo. Córdoba viene desarrollando un trabajo permanente con las pymes ligadas a los centros de investigación y aplicación. Cada año surgen nuevos proyectos de sus “usinas” que generan emprendimientos de calidad, especialmente en el sector de la industria alimentaria.
Entre la infinita variedad de productos clásicos de la provincia se pueden citar los derivados lácteos, los
vinos, los embutidos y sus emble máticos “alfajores cordobeses”. La riqueza de su geografía unida a la belleza de sus paisajes la con virtieron en una provincia elegida para vacacionar. El extraordina rio crecimiento del turismo nacio nal ha demandado el crecimiento del comercio minorista. Hoy, la provincia está desarrollando polí ticas para la renovación de equi pamientos y tecnologías que per mitan producir todo tipo de ali mentos en pequeña y gran escala, que garanticen calidad e inocui dad para poder abastecer tanto a la población como a los turistas que arriban de todas partes del país y del exterior.



La provincia de Córdoba cuenta con un predio ferial de excelencia. El Centro de Convenciones Juan Bautista Bustos está a minutos del aeropuerto y cómodamente emplazado en las avenidas de acceso a la ciudad. Este espacio de exhibiciones es un lugar ideal tanto para exponer insumos y equipamientos como para comprarlos. Quienes lleguen por avión o por tierra cuentan con todas las comodidades para poder dedicarse durante las tres jornadas a la toma de decisiones comerciales. La hotelería ofrece opcio nes para todos los niveles. Publitec está llevando adelante una campaña de comunicación dirigida a todo el banco de datos de visitantes compradores. Para ello cuenta con su propio sistema, alimentado ahora por el caudal de visitantes que llegó a FITHEP Latam en junio pasado. El trabajo en las redes ha ampliado el universo de interesados en pertenecer al rubro. La revista Heladería Panadería Latinoamericana, por su parte, recorre el país y visita a expositores y visitantes informando de forma per manente quiénes expondrán en la feria y cuál será la oferta disponible. Córdoba será una plataforma de negocios para todo el país y el visitante no tendrá tiempo para dedicarse a otra tarea que la de aprove char las oportunidades que encontrará en FITHEP Centro.

Publitec cuenta en Córdoba con el apoyo del CIPAC, Centro de Industriales Panaderos de Córdoba. Esta entidad que representa al empresariado ha manifes tado desde un comienzo su entusiasmo por ver a FITHEP en su distrito. CIPAC está promoviendo junto con Publitec la convocatoria abierta a compradores profesionales dentro y fuera de la provincia y se encuentra comprometida en mostrar el nivel al que ha llegado la industria panaderil local.
Acompañarán esta primera edición de la feria todas las entidades que ya son parte de FITHEP. La Federación de Pasteleros de la República Argentina que nuclea a trabajadores de pastelería, heladería y alfajoreros, entre otros. AFADHYA, la Asociación de Fabricantes de Helados y Afines, estará llevando un certamen inédito en la Argentina, que comunicará
formalmente antes de fin de este año. Esta asocia ción es la responsable de grandes avances en la pro ducción del auténtico helado artesanal y su dinamis mo y eficiencia organizativa la colocan por encima de cualquier par de América latina.
APYCE, la Asociación de Propietarios de Pizzas y Empanadas, es uno de los grandes motores de atrac ción dentro de la feria. En cada edición presenta todas las novedades en relación a elaboración de pizzas, técnicas y productos así como también de empanadas. En FITHEP Centro formará parte de las clases magistrales en donde grandes maestros ofre cerán al público pizzero nuevos modos de hacer y potenciar sus productos.

FAIPA, la Federación de Industriales Panaderos ha aceptado la invitación para ser parte de esta pri mera edición y contará con un espacio para atender a los panaderos de todo el país que lleguen a la feria.


En el lanzamiento de FITHEP CENTRO que tuvo lugar en el pasado de mes de junio, Ana Galibert, una de las

directoras de Publitec, explicó a los presen tes que la feria no es un negocio inmobiliario que “vende metros cuadrados”. Para sus organizadores, esta feria profesional es la propuesta de compartir un tiempo “recortado del calendario”, en donde expositores y compradores viven la experien cia comercial en su punto máximo. En este sentido Galibert destacó que la presencialidad no se discute, “ninguna feria virtual pudo reemplazar el cara a cara en el mundo de los negocios”. Las grandes ferias inter nacionales también se han manifestado en ese senti do y han vuelto con mayor fuerza para ofrecer aún más superficies expositivas para ese encuentro perso nal insustituible.
Asimismo, FITHEP es una instancia de capacita ción. La inmersión en el mundo de las técnicas de elaboración y las nuevas tecnologías genera un espacio para el conocimiento, para la consulta con grandes maestros y con los ingenieros que diseñan los nuevos equipamientos. Es allí donde la feria ofre ce esta posibilidad de contactos múltiples, tanto en las clases magistrales como en cada stand en donde se ponen en funcionamiento las máquinas, se expli can los procesos y se reelaboran los modelos de negocios en el dinámico mundo de la gastronomía.
La VIII edición presentó propuestas innovadoras para la industria de alimentos
Con el declarado objetivo de contribuir al desarrollo de nuevos alimentos y tecnologías en los procesos productivos y de promover la vinculación y transferencia tecnológica entre los secto res científico e industrial, se desarrolló en la ciudad de Córdoba el Congreso Internacional de Ciencia y Tecnología de los Alimentos Córdoba 2022 (CICyTAC). El encuentro, organizado por el Ministerio de Ciencia y Tecnología provincial (MINCYT) y el Centro de Excelencia en Productos y Procesos de Córdoba (CEPROCOR), tuvo lugar del 4 al 6 de octubre en el Centro de Convenciones “Brigadier General Juan Bautista Bustos”.
Luego de ocho exitosas ediciones, el CICyTAC se ha consolidado en el ámbito científico, tecnológico y socio-productivo como una referencia a nivel provincial, regional e internacional. En esta opor tunidad, el acontecimiento congregó a 1200 inves tigadores que pudieron compartir experiencias y saberes y escuchar a 38 conferencistas provenien tes de nuestro país, España, Brasil, México, EE.UU., Canadá, Italia y Dinamarca. Con más de 900 traba jos en formato de póster y 90 presentaciones ora les, el CICyTAC fue un encuentro vivo y dinámico, propicio para el debate e intercambio de experien cias y actualización de avances en ciencia, tecnolo gía e innovación en el área de los alimentos. . Los organizadores también pusieron el acento en la
aplicación de los conocimientos desarrollados por el sector académico, por lo que, además del enfo que práctico de las conferencias, se prepararon talleres con participación de actores a la industria y la Expo Feria FoodTech, un espacio destinado a fir mas proveedoras de insumos, equipos, servicios y productos y a industrias de los alimentos. Asimismo, se implementó un espacio de “networ king” para el intercambio entre las empresas, mar cas e instituciones que buscaban ofrecer sus pro ductos o servicios.
El coordinador del Comité Organizador, Gabriel Raya Tonetti, expresó que “Desde el año 2004 en forma ininterrumpida aunamos los esfuerzos de ins tituciones académicas, el sector privado y el

Gobierno de la provincia de Córdoba para llevar adelante esto propuesta que ya es una verdadera política pública cordobesa. Con estas acciones, la ciencia y tecnología se ponen al servicio de bús queda de soluciones a los nuevos desafíos que enfrentan los sectores socio-productivos” , y recordó que “Para la provincia de Córdoba es fundamental el sector de alimentos, casi el 38% del producto bruto geográfico está respaldado por la transformación de materias primas en ali mentos”.
Por su parte, el Ministro de Ciencia y Tecnología de Córdoba Pablo De Chiara, Presidente del Congreso, describió que “Esta edición presencial no sólo incluye las tradicionales presentaciones -orien tadas al impacto real en la industria- sino que tam bién profundiza el aspecto estratégico de la ciencia y la tecnología y la innovación en el diseño de ali mentos y en la comprensión de las nuevas tenden cias, tanto en la producción como en el consumo. Y también el aprovechamiento de los subproductos para atender a las cuestiones de la economía circu lar y lograr una producción más sostenible”.

En esa dirección, esta edición del CICyTAC innovó en su formato con la realización de talle res que buscaron llegar en forma específica a un público empresarial y generar un impacto real en la industria. Luego de charlas de expertos que actuaban como disparadores, se abría un espacio amplio para el intercambio de ideas y de caminos de innovación, con presentación de conclusiones, Estos talleres gratuitos, que reunieron a empre sas del sector, consultores y profesionales espe cializados en vinculación tecnológica, estuvieron orientados uno a la producción cárnica sustenta ble y el otro en la formulación de alimentos salu dables en perspectiva del etiquetado frontal de alimentos.
La exitosa organización de este congreso puso de manifiesto la continuidad de una política de estado provincial donde se toma a la ciencia, la tecnología y la economía del conocimiento como promotores de la sustentabilidad y competitivi dad en un sector de relevancia global.




“Hay inscriptos 1.200 participantes, pero hay más asistentes debido a las actividades que se desarrollan en el encuentro”
Para los contenidos del Congreso, en primer lugar, nos basamos en la experiencia. Esta es la octava edición del CICyTAC y tratamos de incorporar todas las áreas de la cien cia y la tecnología de los alimentos. Si bien esta edición es un poco más comprimida que en otras ocasiones, hemos logra do atraer a especialistas de todas las áreas relacionadas con este sector, desde lo microbiológico, lo tecnológico, lo senso rial, aspectos sociales que tienen que ver con la distribución de los alimentos, alimentos saludables, economía circular, etc. Todos esos aspectos intentamos tenerlos en cuenta a la hora de elegir a los conferencistas. Una particularidad de esta edición es que la mayor parte de los disertantes propo nen un perfil de aplicación práctica de resultados. Creemos que es una consecuencia de la pandemia donde se han visto que los resultados generados por los investigadores fueron utilizados de diversas maneras. Además, en forma paralela al congreso hay un taller con la industria cárnica y otro sobre rotulado nutricional, actividades donde participan más industriales que investigadores.





Agricultores, productores, procesadoras de alimentos, empacadoras y comercios pueden pensar que la sostenibilidad no tiene nada que ver con ellos, que es algo que solo tiene importancia para las grandes corporaciones o que ser sostenible es sólo una moda pasajera. Pero tildar de irrelevante a la sostenibilidad puede pagarse muy caro. Cuando las empresas actúan de forma sostenible, los beneficios no sólo redundan en la sociedad, también ayudan a atraer nuevos negocios. Stefaan Kennis nos explica cómo y por qué la tecnología puede facilitarlo.
Lejos de ser una moda, la sostenibilidad ha llegado para quedarse y tiene cada vez más importancia, especialmente en sectores de venta directa al con sumidor final. Como el consumidor es cada vez más consciente sobre asuntos como la sostenibilidad, el medio ambiente y el trato justo a los trabajadores, espera que las marcas traten estos temas de forma responsable y ética; justo lo mismo que las marcas esperan de sus proveedores. Todo esto puede pare cer una carga no deseada para algunas empresas, pero la responsabilidad siempre tiene su recom pensa. Si se toman en serio la sostenibilidad empresarial, las compañías que realizan su activi dad cara al público pueden aumentar la fidelidad de sus clientes y su cuota de mercado. En definiti va, el sector alimentario puede competir de mane ra más eficaz por contratos de esas empresas si entiende que sus propias acciones también pueden
incorporar la sostenibilidad. Así que veamos de qué manera la sostenibilidad, además de ser un benefi cio para la sociedad en general, también puede ser buena para el comercio, cómo puede integrarse en el sector alimentario y a qué actividades empresa riales puede aplicarse.

Cada vez son más los consumidores que reflexionan sobre las compras que hacen y se preocupan en informarse sobre si el producto se ha producido de forma sostenible y responsable con el medio ambien te. Estas actitudes varían de país a país, de genera ción a generación e incluso de un sector a otro, pero la sostenibilidad es un criterio importante a la hora de comprar un producto para el 60% de los consumi dores. Esta es una de las conclusiones del Global Sustainability Study 2021, elaborado por la consulto
ría Simon-Kucher&Partners, que también reveló que más de un ter cio de los consumidores de todo el mundo está dispuesto a pagar pre cios más altos por productos soste nibles y, en los últimos años, un 85% ha pasado a realizar compras más ecológicas.
Este estudio, al igual que otros anteriores, indica que los consu midores menores de 40 años están más concienciados sobre estos temas que los de generacio nes mayores. Cuanto más joven es la persona, más conciencia tiene de las consecuencias que sus decisiones de compra tienen en el mundo y mayor probabilidad de que se decante por marcas con cuyas causas sociales esté de acuerdo. Esto es ya muy importante, pero lo será aún más en el futuro cercano: cada año, las generaciones jóvenes (conocidas en el mundo del marketing como millennials y generación "Z") constituirán una proporción cada vez mayor del total de consumidores.

La opinión pública o los peligros del cambio cli mático no son los únicos motivos que están impul sando la sostenibilidad en el mundo empresarial. Otro factor muy importante son las redes sociales. Las plataformas online dan a cualquiera que no esté contento con algo el poder de dejar una crítica de grandes repercusiones. El éxito comercial hoy en día no depende únicamente de ganarse el cora zón y la cabeza del consumidor, sino también de no defraudarlo ni ofenderlo. Aquellas empresas que no presten atención a la sostenibilidad (por no pre ocuparse del medio ambiente o desperdiciar recur sos finitos) pueden perder rápidamente el favor de los consumidores de los que depende su propia existencia.
El lado positivo es que para el sector agroalimenta rio es muy fácil tomarse en serio la sostenibilidad, ya que se lo facilitan las tecnologías de TOMRA Food, fabricante mundial líder en soluciones de clasifica ción basada en sensores y soluciones integradas
postcosecha. Las clasificadoras TOMRA son capaces de detectar y expulsar de la línea de producción y procesado material extraño según color, forma, tamaño, estructura y hasta sus características bioló gicas, y son famosas por establecer unos estándares muy altos en cuanto a seguridad alimentaria y cali dad de los productos. Menos conocido es, sin emba rgo, que las soluciones TOMRA también ayudan a lograr la eficiencia ecológica. Además, pueden per sonalizarse para prácticamente cualquier tipo de alimento: papas, verdura, fruta fresca o procesada, frutos rojos, fruta deshidratada, frutos secos, semi llas y cereales, proteínas, alimentos para mascotas y golosinas.
Reducir la pérdida y el desperdicio de alimentos es clave para disminuir los costos de producción y aumentar la eficiencia del sistema alimentario, mejorar la seguridad alimentaria y la nutrición y contribuir a la sostenibilidad medioambiental. La pérdida de alimentos se produce a lo largo de toda la cadena de suministro, desde la postcosecha -en la propia explotación- hasta que llegan al comercio para su venta (sin incluir la que ya se produce en el propio comercio). El desperdicio de alimentos alude a los alimentos que se descartan en los comercios, proveedores de servicios alimentarios y a nivel del consumidor en sí.
Las soluciones actuales de clasificación y calibra do mejoran el rendimiento y la rentabilidad median te la reducción de la pérdida de alimentos (algo cada vez más urgente). La sostenibilidad y la super vivencia están vinculadas de forma indisoluble:
según la Organización de las Naciones Unidas para la Alimentación y la Agricultura (FAO), para el año 2050 la demanda de alimentos aumentará un 50% a pesar de que el terreno productivo sólo aumentará un 20%. Por ello, resulta necesario utilizar de forma mucho más eficaz los recursos existentes.
Una vez más, la tecnología tiene la solu ción. Un informe reciente del Parlamento Europeo ('Technology options for feeding 10 billion people', 'Opciones tecnológicas para alimentar a 10.000 millones de personas') indica que la sostenibilidad puede mejorarse de muchas for mas diferentes automatizando la producción de ali mentos y las líneas de procesado. Según el informe, entre las ventajas de la automatización se encuentran la "optimización de la calidad de los productos" y la "reducción de las pérdidas de calidad y los defectos". Sin duda, ambas ventajas se cumplen según la expe riencia de TOMRA. Las clasificadoras y calibradoras de TOMRA Food están diseñadas (y perfeccionadas in situ) para eliminar materiales no deseados y produc tos imperfectos sin necesidad de desechar alimento alguno. Las soluciones TOMRA ofrecen una ratio extremadamente baja de producto bueno dentro de producto malo. Además, si la línea expulsa en algún momento producto bueno, suele poder recuperarse al pasarlo una segunda vez por una clasificadora. De esta forma se aprovecha, para su venta, junto a un producto secundario de calidad inferior. Por ello, las soluciones de clasificación y calibrado TOMRA aumentan la rentabili dad de la producción, son una medida en favor de la sostenibilidad y ofrecen a sus usuarios una enorme ventaja competiti va al disminuir los reprocesos, que van de la mano con mayor uso de recursos tales como la energía.

Reducir aún más la pérdida de alimen tos sería muy positivo, sobre todo por que estamos entrando en la era de la
digitalización. Un buen ejemplo es la forma en que las clasificadoras TOMRA se conectan a la platafor ma de datos TOMRA Insight, que recoge datos casi en tiempo real y los almacena de forma segura en la nube. Los datos recogidos pueden tener respuesta inmediata (y remota) para optimizar la configura ción de la máquina y los datos históricos pueden convertirse en información que permite mejorar el rendimiento. Dicho análisis de datos tendrá cada vez más valor conforme avancemos a un futuro más digitalizado, que transformará la clasificación y el calibrado de meros procesos operativos a una herra mienta de gestión estratégica. En definitiva, esfor zarse en adoptar prácticas sostenibles no es tan dife rente de invertir en soluciones TOMRA ya que, ade más de ser bueno para el planeta, ayuda a proteger el activo más valioso de una empresa, el prestigio de la marca.

TOMRA Food diseña y fabrica máquinas de clasificación basadas en sensores y soluciones inte gradas de postcose cha que transforman la producción mundial de ali mentos para maximizar la seguridad y minimizar el desperdicio, asegurándose que "Cada Recurso Cuenta". Entre ellas se incluyen las soluciones más avanzadas de calibrado, clasificación, pelado y tecnología analítica, que mejoran la rentabilidad, permiten alcanzar mayor eficiencia operativa, y un suministro alimentario seguro. La empresa tiene más de 12.800 unidades instaladas por todo el mundo en productores, envasadores y procesado res de dulces, fruta, fruta deshidratada, cereales y semillas, papas, proteínas, frutos secos y verdura. TOMRA Food cuenta con centros de excelencia, ofi cinas regionales y plantas de fabricación en EE.UU., Europa, Sudamérica, Asia, África y



Australasia. Se puede seguir a TOMRA Food en Facebook (TOMRA.Food), Twitter (TOMRAFood), Instagram (TOMRAFood) y LinkedIn (TOMRA Food).
TOMRA Food forma parte de TOMRA Group. TOMRA se fundó en 1972 en base a una idea innova dora que comenzó por el diseño, la producción y venta de máquinas de devolución de depósitos (MDD) para la recolección automatizada de envases usados de bebidas. Hoy TOMRA lidera la revolución para transformar la forma en que se obtienen, apro vechan y reutilizan los recursos del planeta para lograr así un mundo sin residuos. La compañía cuen ta con otras divisiones que son TOMRA Recycling, TOMRA Mining y TOMRA Collection. TOMRA dispone hoy de unas 100.000 instalaciones en más de 80 mer cados a nivel mundial y sus ingresos totales en 2021 alcanzaron 10.900 millones de NOK. El grupo tiene unos 4.600 empleados a nivel global y cotiza en la Bolsa de Valores de Oslo. La central de la compañía se encuentra en Asker, Noruega.


Cumple cien años ofreciendo al mercado argentino colorante caramelo líquido y caramelo líquido de máxima calidad

El colorante caramelo es un ingrediente importantísimo para la industria de alimentos y bebidas, con múltiples aplicaciones que van desde las bebidas sin alcohol y licores hasta los postres y helados. Su demanda está asegurada, pero con una condición: debe ser de alta calidad y cumplir con los requerimientos y estándares de cada cliente. El mercado argentino cuenta con este ingrediente desde hace cien años gracias a Antonio Bacigalupo, un pionero genovés que comenzó a elaborarlo en 1922. Hoy la empresa que fundó es una pyme familiar centenaria que continúa proveyendo colorante caramelo líquido clase I y caramelo líquido de origen natural con el respaldo de certificaciones de gestión de calidad e inocuidad reconocidas internacionalmente.
Con el paso de las décadas, Alimentos Bacigalupo –hoy conducido por Karina Bacigalupo, bisnieta del fundador– se ha especializado en la producción de la más alta calidad de colorante caramelo y de cara melo líquido de origen natural. La empresa ha sabi do adaptarse y crecer, certificando normas de cali dad que le permiten acceder con sus productos a toda la industria alimentaria, desde pequeñas
pymes hasta grandes multinacionales elaboradoras de bebidas y alimentos.
Ese crecimiento también obligó a sucesivas mudanzas: desde la fábrica original, en el barrio de La Paternal, pasó a la planta en el barrio de Versalles -donde en la década del ’50 lanzó el cara melo líquido para repostería- y de allí a la actual planta en 9 de Julio 2189, en Ciudadela, provincia
de Buenos Aires, donde cuenta con mayor capacidad, amplios depósitos y un labora torio propio. El carame lo líquido para reposte ría fue un desarrollo de Antonio Juan Bacigalupo, nieto del fundador y padre de la actual presidenta, que resultó un producto de enorme éxito y que hoy se sigue distribuyendo a todo el país.



El compromiso con los clientes, el buen clima laboral con traba jadores de larga trayecto ria, y la fluida comunicación entre directivos, empleados y clientes han sido claves para construir esta historia cente naria, no exenta de altibajos por las varias crisis económi cas del país, y sostener hoy una empresa sólida y confia ble.
Los productos de Bacigalupo presentan una etiqueta limpia, sin gluten, sin alérgenos y libres de OGM , lo que los posiciona en forma ventajosa ante los cambios en las exi gencias de los consumidores. La dedicación casi artesanal con que son elaborados, sumada a los estándares estable cidos para garantizar productos de calidad, inocuos y acordes a las necesidades tecnológicas de cada cliente, y a la actitud de una Dirección dispuesta a incorporar for mación y destinar recursos para una mejora constante, explican la vigencia de la empresa.
 LA
LA
Se trata de un jarabe de azúcar caramelizada que provee de sabor dulce y color a alimentos y bebi das. Ideal para utilizar en productos naturales. Se puede variar la intensidad del sabor dulce y la intensidad del color, ya que son compatibles con los colorantes caramelo. Hay muchas consideracio nes en la elección de l producto para su aplicación específica. El equipo técnico de Bacigalupo está dis ponible para ayudar a elegir el color o caramelo más adecuado para satisfacer las necesidades de cada cliente. En condiciones normales de manipu leo y conservación el producto se mantiene inalte rable por 24 meses.
Presentación: Frascos 130 g - Pomos de 450 gBotella de 1.250 kg - Bidones x 7 y 30 kg - Baldes x 30 kg - Contenedores de 1500 kg - A Granel
Se trata de un colorante Clase I (denominación euro pea E150a) elaborado únicamente con azúcar de caña, utilizado para dar color a alimentos y bebidas, alimentos para mascotas y aplicaciones farmacéuti cas y cosméticas, entre otras.

No se trata de aportar sabor sino simplemente es un agente colorante. Cuando se utiliza en con centraciones bajas, no afecta el perfil de sabor del producto terminado. Los Colores Caramelo Clase I satisfacen la demanda de los consumidores por una etiqueta más limpia en los alimentos y bebi das que consumen. Hay muchas consideraciones en la elección del producto para su aplicación específica. El equipo técnico de Bacigalupo está disponible para ayudar a elegir el color más ade cuado para satisfacer las necesidades del cliente. En condiciones normales de manipuleo y conser vación el producto se mantiene inalterable por 24 meses.
Presentación: Botella de 1,25 kg - Bidones x 7 kg - Bidones x 29 kg - Baldes x 29 kg - Contenedores de 1500 kg - A Granel





Durante muchos años la limpieza y sanitización de los alimentos estuvo basada únicamente en formulacio nes adaptadas, que sólo habían sido diseñadas para uso en superficies. Con el tiempo, se fueron mejorando y desarrollando diferentes caminos tecnológicos que permitieron acceder a nuevas propuestas y tecnologí as, las que abrieron un camino para eliminar o dismi nuir notoriamente las cargas microbianas en alimen tos frescos y procesados, minimizando el riesgo de las enfermedades trasmitidas por los alimentos (ETA).
Victory Limpieza Profesional incursionó en estas tecnologías innovadoras con el desarrollo de tres líneas de sanitizantes. Todas tienen características diferentes, con objetivos concretos:
• Disminuir la carga microbiana en los alimentos y aumentar su vida útil, permitiendo su aptitud para el consumo y asegurando la inocuidad alimentaria.

• La utilización de ingredientes efectivos pero que también están alineados a las necesidades y tenden cias de los nuevos consumidores, es decir productos “eco friendly”, ecológicos y sostenibles en el tiempo.
El departamento técnico de Victory Limpieza Profesional puso énfasis en las necesidades de los consumidores, de los empleados que procesan los alimentos y de las empresas alimentarias para ofre cer al mercado productos más eficientes, seguros y de fácil manejo.
Líneas de sanitizantes para frutas, verduras y hortalizas
Es un desinfectante de agua de lavado para fru tas, verduras y hortali zas a base de ácido peracético concentrado y estabilizado. Posee un efecto dual como desin fectante: actúa sobre la pared celular inhibiendo la reproducción de los microrganismos, al tiempo que oxida la materia orgánica, fuente de alimento de los mis mos. Además inactiva todo tipo de plagas, como moscas blancas, pulgón, parásitos, orugas, gusanos grises, larvas, etc. Se trata de un producto totalmente “eco friendly”, ya que en su descomposición genera sólo oxígeno y ácido acéti co, ambos amigables con el medio ambiente.

- Inactiva instantáneamente todo tipo de plaga.
- Sostenible y amigable con el medio ambiente.
- No deja residuos de sabor ni olor.
- No requiere enjuague.
Desinfectante de base clorada para agua de lavado en frutas, verdu ras y hortalizas.

Producto líquido con centrado de muy senci lla manipulación y de alta pureza; combinado con estabilizantes y adi tivos que aseguran una efectiva desinfección en todo tipo de vegetales y frutas. Posee una acción oxidativa sobre las pare des celulares y de blan queo sobre los colorantes orgánicos presentes en las aguas. Su amplio espectro de acción mejora la cali dad de los alimentos, aumentando su vida útil.
- Efectivo inclusive para aguas duras.
- Fórmula estabilizada.
- Amplio espectro de acción.
Desinfectante de agua de lavado para frutas, verduras y hortalizas a base de ácido láctico y un buffer de pH controla do. Posee acción inme diata sobre los microor ganismos que causan enfermedades de origen alimentario (ETA). Inhibe el crecimiento de las bacterias que degradan los alimentos sin afectar el gusto, el olor ni los colores de los mismos, mejorando el aspecto superficial en sólo 90 segun dos. Es ideal para uso en empresas de catering, plan tas citrícolas, plantas de procesamiento de pasas de uva, arándanos, brócoli, coliflor, manzanas, naran jas, ciruelas, ajíes, etc. Luego de su aplicación no es necesario enjuagar debido a que el ácido láctico es considerado de grado alimenticio, ya que se trata de un compuesto natural que se encuentra en los proce sos de fermentación de muchos alimentos y forma parte del metabolismo celular.



Producir ingredientes listos para consumir que incorporen nutrientes alternativos es una tendencia indiscutible. Cada nueva incorporación representa un desafío a la hora de su proceso, incluyendo la reducción de tamaño, entre otros. La lista parece incrementarse en forma indefinida a medida que la industria responde a la intención de sus clientes de incorporar alimentos funcionales, tales como remolacha, algas, coliflor, proteína de arvejas, semillas de lino y otras alternativas a las proteínas animales, incluyendo insectos. Urschel ofrece una amplia gama de equipos para el proceso de estos alimentos alternativos en sus distintas etapas, ya sea producto fresco, deshidratado o extruido.
Hay que tener claro cuál es la mejor opción para un producto según las características de sus ingredien tes. En algunos casos se puede cortar el producto deshidratado a granel. En otros, el fabricante prefie re procesarlo en un lecho fluido, y otros prefieren cortarlo en su estado natural para después secarlo. Para la reducción de tamaño de partícula, el modelo Comitrol de la línea de molinos Urschel se ofrece como una solución para una amplia gama de pro ductos, tanto secos como semisecos o líquidos. La línea de Comitrol ofrece tolva, conexión para bom bas o tornillo de alimentación para adaptarse a la línea y la condición de la materia prima. La elección del cabezal de corte e impulsor, así como la veloci dad de éste, determinarán el tamaño de partícula final, pudiendo obtenerse desde un granulado uni forme a una pasta uniforme de partícula impalpable. Esta línea de equipos también ofrece distintas tolvas de descarga para una mejor integración a su línea.

También es importante tener en cuenta las caracte rísticas de cada producto durante su proceso. Cuando se trabaja en seco es fundamental mante ner constantes los valores de humedad del ingre diente para asegurarse un resultado consistente. También es importante tener en cuenta que los productos secos pueden producir un polvo infla mable e incluso explosivo. Muchos fabricantes optan por procesar el producto en un medio líquido y luego secarlo. El proceso en medio líquido cono cido como “Slurry” emplea en ocasiones agua para facilitar la reduc ción del ingrediente y asegurar máximo rendimiento, en otras ocasiones la misma humedad del producto es la que aporta el

medio líquido para el proceso. Algunos productos, como el caso de las algas o el coliflor, requieren un pre-corte en fresco que puede ser utilizado como tal, o continuar luego a un proceso de molienda final en su estado natural, en lecho fluido o secarlo.


Un pre-corte de precisión y un corte uniforme en cada una de las etapas del proceso reduce el desperdicio e incrementa el rendimiento. Para cada etapa del proceso de reduc ción de tamaño, Urschel puede ofrecer un equipo que se ajusta a las necesidades. Desde cubicado
ras como la DiversaCut Sprint o 2110 -capaces de obtener cortes de hasta 3 mm de producto fresco- o molinos de la línea Comitrol para la obtención de partículas microscó picas, hasta cortadoras como la M6 capaz de obtener desde cubos a desmenuzados de extruidos de proteína de base vegetal. En Urschel los interesados siempre contarán con un asesor para encontrar la solución más eficiente para su línea de proceso.


La ingesta de fibras de raíz de achicoria aumenta las bifidobacterias y favorece la función intestinal

Una nueva revisión bibliográfica sistemática con metaanálisis, realizada por Dávid U. Nagy et al. , demuestra que la ingesta de fibra de raíz de achicoria (a partir de 3 g/día) promueve un crecimiento significativo de las bifidobacterias en el microbioma intestinal en todos los grupos de edad y mejora los parámetros de la función intestinal. Es el primer estudio de este tipo, basado en ensayos de control aleatorios, que ha investigado el efecto de los fructanos de tipo inulina derivados de la raíz de achicoria sobre la abundancia de bifidobacterias en la microbiota intestinal y los resultados relacionados con la salud.
En la revisión sistemática con metaanálisis, conside rada la metodología más sólida en la jerarquía de la evidencia científica, se incluyeron 50 estudios de intervención en humanos, con un total de 2.495 par ticipantes. Se seleccionaron sobre la base de un amplio proceso de búsqueda y revisión de la biblio grafía que siguió las directrices del Manual Cochrane de Revisiones Sistemáticas de Intervenciones. Esta investigación evidenció que la inulina, la oligofructo sa y sus combinaciones, derivadas de la raíz de achi coria como fuente de origen, actúan como factor bifi
dogénico, promoviendo el crecimiento selectivo de las bifidobacterias. La revisión sistemática con metaanálisis también demuestra que la fibra de raíz de achicoria es un prebiótico que cumple con la defi nición de prebiótico de la ISAPP (Asociación Científica Internacional para Probióticos y Prebióticos).
Los investigadores informaron además de que los efectos bifidogénicos de las fibras de raíz de achico ria iban acompañados de una mejora de la regulari dad intestinal. Esto fue validado por el aumento de la frecuencia de las deposiciones en adultos sanos y
por las heces más blandas en bebés y niños sanos. Al comentar los resultados, Anke Sentko, Vice President Regulatory Affairs & Nutrition
Communication de BENEO, asegura: "Me complace enormemente que se haya llevado a cabo esta deta llada revisión sistemática crítica con metaanálisis. Siguiendo la metodología de pruebas científicas de máxima calidad, se confirma el efecto prebiótico de los fructanos de tipo inulina procedentes de la raíz de achicoria. Se demuestra una vez más que la integra ción de las fibras de la raíz de achicoria en la dieta diaria de una persona favorece a las bifidobacterias y, por tanto, a su microbioma intestinal, al tiempo que mejora las funciones intestinales desde los más jóve nes a los más mayores".
Las fibras prebióticas de BENEO, Orafti®Inulina y Oligofructosa, son fructanos de tipo inulina. Se trata de fibras prebióticas naturales, no modificadas gené ticamente y de etiqueta limpia, que se obtienen de la raíz de achicoria mediante un suave método de extracción con agua caliente, a diferencia de otras fibras de fabricación artificial o química. Pueden utili zarse en una ampli a gama de aplicaciones de alimen tos y bebidas, incluidos los alimentos para bebés, de acuerdo con las legislaciones nacionales. Como pre bióticos probados, las fibras de raíz de achicoria (inuli na, oligofructosa) favorecen una microbiota intestinal sana y promueven selectivamente el crecimiento de microorganismos beneficiosos, como las bifidobacte rias, en el intestino. Las fibras de la raíz de achicoria son el alimento preferido de esos microorganismos buenos y, por tanto, los ayudan a crecer y multiplicar se. Debido al aumento del metabolismo bacteriano en el intestino grueso, se mejora la regularidad.


Nagy DU, Sándor-Bajusz KA, Bódy B, Decsi T, Van Harsselaar J, Theis S & Lohner S (2022) Effect of chicory-deri ved inulin-type fructans on abundance of Bifidobacterium and on bowel function: a systematic review with meta-analyses. Critical Reviews in Food Science and Nutrition. Publicado el 14 de julio de 2022, DOI: 10.1080/10408398.2022.2098246
Higgins JPT, Thomas J, Chandler J, Cumpston M, Li T, Page MJ, Welch VA (editores). Cochrane Handbook for Systematic Reviews of Interventions version 6.3 (updated February 2022). Cochrane, 2022. Disponible en www.training.cochrane.org/handbook
MÁS INFORMACIÓN: www.beneo.com y www.beneo.com/news Twitter: @_BENEO LinkedIn:www.linkedin.com/company/beneo
Las premezclas hoy son una herramienta esencial para todo tipo de panaderías, desde las más pequeñas hasta para las grandes. Son soluciones que permiten a los panaderos elaborar de manera sencilla y rápida una amplia gama de panes especiales, baguettes de gran sabor, productos de repostería y bollería con la garantía de una calidad constante, resultando más económicas que el uso de los ingredientes por separado.

Las premezclas en panadería se definen como la mez cla de ingredientes básicos y específicos, tales como harina base (trigo, salvado, centeno u otra), sal, azú car, levadura y/o agentes leudantes químicos, leche en polvo, emulsionantes y enzimas, entre otros. Con el agregado de otros pocos ingredientes (agua, acei te, huevo) y siguiendo las instrucciones básicas de uso del fabricante, se obtienen horneados similares a un panificado artesanal de buen sabor, desarrollo y con una regularidad constante en la calidad del pro ducto final. Por lo general estas soluciones se dosifi can entre el 10% y el 50%. Al contener un poco de harina de base, el panadero debe completar su pre
mezcla con harina e incorporar agua, sal y levadura durante el amasado.
Las premezclas buscan minimizar los tiempos de los procesos operativos y sus costos asociados, per mitiendo reducir el número de materias primas que entran en juego durante la elaboración clásica, cola borando con la ganancia de tiempo y limitando los riesgos de errores durante la elaboración. Actualmente se pueden encontrar en el mercado dife rentes premezclas para productos de panadería, como pan blanco, pan de Viena, prepizzas, facturas, cookies, bizcochuelos, budines, brownies, pan dulce, entre otros.
- Garantizan calidad constante y resultados homogéneos, asegurando un idéntico perfil técnico y organoléptico (sabor, esponjosidad, suavidad, uni formidad, vida útil).
- Resuelven el desarrollo de fórmulas, ya que incluyen los ingredientes necesarios y en sus justas cantidades, incluyendo mejoradores de masa y mini mizando así los errores en el pesado.
- Simplifican la compra de materias primas, ya que se reducen considerablemente.
- Ofrecen resultados comprobados y horneado esperado, sin fallos, siempre que se sigan los pasos del modo de preparación.
- Permiten la optimización y conveniencia en el manejo de stocks ya que ahorran espacio y se con servan mejor.
- Contribuyen a reducir los tiempos productivos dado que los ingredientes están pre-pesados, con trolados y hay menos manipulación.

- Aseguran facilidad y rapidez de uso.
La salud se ha convertido en un eje fundamental en las decisiones de compra de los consumidores y la industria elaboradora de harinas y panificados no es ajena a esta tendencia. Los fabricantes deben res ponder a las necesidades de consumidores cada vez más informados y preocupados por lo que consu men. Para poder diferenciarse y destacarse en las góndolas de un mercado cada vez más competitivo, es clave ofrecer alternativas de productos con un mejor perfil nutricional. Desarrollar formulaciones y elaborar panes con alto contenido en fibras, con harinas alternativas o integrales, con masa madre y con el agregado de diferentes semillas enteras los hace especiales, más ricos y saludables.
La elaboración de panificados con materias pri mas distintas a las convencionales resulta un gran desafío para la industria, siendo las premezclas solu ciones versátiles, completamente balanceadas y pre cisas para desarrollar nuevos productos de manera segura y rápida, ya que minimizan los errores durante el proceso y garantizan que la elaboración -siguiendo las recomendaciones de uso y receta- resulten en un pan de primera calidad.
Con el objetivo de desarrollar soluciones integrales y que permiten elaborar panificados premium con características artesanales, el Centro Tecnológico Granotec lanzó al mercado los nuevos núcleos GranoMix Nutrivida para la industria y panaderías que dan respuesta a las nuevas tendencias y reque rimientos de consumo saludable. Estas mezclas requieren el agregado de harina, agua, levadura y sal. Gracias a su formulación 30%, el fabricante o panadero profesional podrá seleccionar la harina base que se adecue a sus especificaciones, variar el sabor y originalidad de su producto final agregando los ingredientes específicos a su gusto. Algunas de las alternativas disponibles son:
Para elaborar panes con harina de grano entero y salvado de trigo, centeno, avena y cebada + avena arrollada + masa madre + semillas de girasol y lino.
- GranoMix Nutrivida Grano Entero
Para fabricar panes con harina de grano entero, sal vado de trigo + masa madre.
- GranoMix Nutrivida Semillas Plus
Para producir panes con harina de grano entero de trigo y cebada + avena arrollada + siete semillas (sésamo, amaranto, chía, zapallo, lino, amapola y girasol) + masa madre.
Para desarrollar panes con harinas de legumbres y trigo sarraceno + masa madre + semillas de girasol y zapallo.
Para hacer panes con harina de grano entero, malta y centeno + masa madre + semillas de girasol.
A modo de ejemplo se detalla una receta convencio nal de pan de molde:

GranoMix Nutrivida 1 Kg Harina 000 2 Kg Agua (60%) 1.8 Kg Levadura seca (1%) 30 g Sal (2%) 60 g





Según sea el núcleo que se utilice, como ventaja dife rencial se podrán incluir ciertas declaraciones en los envases de los nuevos productos: Con masa madreCon grano entero - Fuente de fibra - Fuente de proteína - Con legumbres - Con semillas – Multicereal – Integral.
El Centro Tecnológico Granotec pone a disposi ción de los clientes la experiencia de sus especialis tas para evaluar sus requerimientos y recomendar las premezclas específicas para ampliar su línea de productos, creando y elaborando de manera rápida y simple panificados más nutritivos y saludables.
María Celeste Borra Tel.: +54 11 3327 44 44 15 al 19 WhatsApp +54 9 11 5595-0841 sac@granotec.com.ar www.granotec.com.ar

En 1972 se crea la Universidad Nacional de Luján, cuyo proyecto fundacional era brindar a la sociedad un conjunto de carreras orientadas a las necesidades regionales y nacionales, teniendo como objetivo el desarrollo económico y social de nuestro país.
El 6 de septiembre de 1973 comienza el dictado de un Ciclo de Formación General, común a todas las carre ras de la Universidad y a mediados de 1974 ya se dic tan los primeros cursos en la flamante carrera de Licenciatura en Transformación de Alimentos, que tenía en su currículo el título intermedio de Técnico Universitario en Transformación de Alimentos. A partir de 1977 se produjo el cambio del plan de estudios que transformó la Licenciatura en Ingeniería en Alimentos, siendo junto con San Rafael en Mendoza y Concordia en Entre Ríos las pioneras en el país. En 1980 se reci bieron los primeros Ingenieros en Alimentos que cur saron en Luján pero que se recibieron como UBA: Ricardo Anselmo, Nidia Giordano, Mario Ismach, Héctor Kleiman, Itatí Lausada, Jorge Naiman, Alejandro Roberti y Mario Sadras. El impacto de la carrera fue, desde el comienzo y a pesar de las vicisitu des, mayor que lo esperado. Los técnicos e ingenieros egresados de Luján se desempeñan con notable éxito y suficiencia en gran diversidad de tareas y en diferen tes lugares de la Argentina y del mundo.
El plan de estudios rediseñado en 1984 fue objeto de revisiones desde su comienzo, máxime cuando en la década de 1990 se establecieron los procesos de acreditación que exigían que las carreras de ingenie ría debían optimizarse en los cinco años de duración,
lo que había convertido a la de Luján en una de las dos ingenierías con planes de estudios más extensos del país. A pesar de todo ello, la carrera fue sometida a los procesos de acreditación en forma satisfactoria.

Finalmente en 2022, el Consejo Superior aprueba un nuevo plan de estudios, que reorienta el perfil del ingeniero a los requerimientos sociales de nuestra Argentina, protege las necesidades académicas de los futuros ingenieros y permite encarar un nuevo proce so de acreditación que se llevará a cabo en breve.
El próximo 11 de noviembre de 2022 en la sede se llevará a cabo un encuentro de camaradería de egresados, docentes y estudiantes para celebrar 45 años contribuyendo al desarrollo del país.
LA
Una mirada integral a los sistemas alimentarios 15 al 18 de noviembre de 2022 en Medellín, Colombia
El objetivo general es ofrecer un espacio de encuen tro e intercambio entre los diversos actores que par ticipan en la creación y desarrollo de sistemas ali mentarios, con el fin de contribuir al avance de la gestión de la ciencia, la tecnología, la nutrición e ino cuidad de los alimentos, como factor fundamental de la productividad, competitividad y sostenibilidad de organizaciones, sectores, regiones y países. Los ejes temáticos a desarrollar serán cuatro: “Nutrición, alimentación y salud”; “Ciencia y tecnología de los alimentos”; “Inocuidad alimentaria”, y “Cambio cli mático y gestión de data alimentaria”.
16 de noviembre -El nuevo enfoque de nutrición y salud: el reto actual para el desarrollo de ali mentos y bebidas. Alimentación y nutrición son parte esencial de los Objetivos de Desarrollo Sostenible (ODS). Los avances en el conocimiento
La Asociación Colombiana de Ciencia y Tecnología de Alimentos (ACTA), el programa de Ingeniería Agroindustrial de la Universidad Pontificia Bolivariana, la Asociación Latinoamericana y del Caribe de Ciencia y Tecnología de Alimentos (ALACCTA) y la Asociación Internacional para la Protección de Alimentos (IAFP) han organizado un gran evento para realizar un intercambio de conocimientos, saberes y experiencias en torno al área de los alimentos. CLAMISA 2022 se realizará en la ciudad de Medellín – Colombia en las insta laciones de la Universidad Pontificia Bolivariana y reunirá tres grandes acontecimientos: XVI CONACTA 2022: Congreso Internacional de Ciencia y Tecnología de Alimentos; XXII Congreso Latinoamericano y del Caribe de Ciencia y Tecnología de Alimentos de ALACCTA y VIII Simposio Latinoamericano de Inocuidad de los Alimentos de IAFP.
sobre el microbioma y el eje cerebro-intestinal han demostrado la estrecha relación entre la nutrición, el sistema inmune, el cerebro y las enfermedades.
El objetivo de esta mesa temática es tener una visión clara de las aplicaciones reales de los nuevos conocimientos en nutrición y salud para el desarrollo de alimentos en Latinoamérica.
18 de noviembre - Seguridad o soberanía alimen taria y nutricional: del discurso a los hechos en postpandemia. El objetivo de esta sala es analizar cómo se ha realizado en Latinoamérica la inversión en I+D, la formación de redes y estrategias para asegurar SAN, la adaptación de políticas, planes de gestión de riesgos y pautas de nutrición; puesto que estas políti cas, inversiones y regulaciones son esenciales para la construcción de economías con seguridad, soberanía alimentaria y nutricional.
16 de noviembre - Nanotecnología y alimentos, ya no es ciencia ficción. El objetivo de esta mesa temática es presentar los recientes desarrollos de la nanotecnología y examinar cómo se pueden aprove char por todos los sectores de la agroindustria para el beneficio de nuestros países.

17 de noviembre - El conocimiento del consumi dor a través del análisis sensorial, una necesidad para la industria de alimentos. La comprensión de la experiencia sensorial de los alimentos y la utiliza ción de esta información en relación con el consumi dor tienen un impacto profundo no sólo en el desarrollo de nuevos alimentos y bebidas, sino tam bién para hacer crecer y mantener la fidelidad de los consumidores hacia una marca a través del tiempo. Los estudios etnográficos, la observación de los con sumidores en vivo y las medidas biométricas de la respuesta de los consumidores frente a un alimento se han vuelto fundamentales en la industria.
17 de noviembre - Sostenibilidad y economía cir cular en el procesamiento de alimentos. La indus tria de alimentos tiene el compromiso de revisar y reducir el impacto ambiental de su actividad econó mica. Este análisis debe ser integral donde la estra tegia de adaptación, diferenciación e innovación se debe centrar en mejores prácticas de procesamien to, diseño de plantas, envases etc. Adicionalmente, es necesario analizar cómo desde la dinámica de economía circular también se está logrando reducir el impacto ambiental y generar otras alternativas para mejorar la competitividad del sector agroali mentario en Latinoamérica.
de noviembre - Análisis y prospectiva de las regulaciones alimentarias en Latinoamérica. El objetivo de esta sala es entender cómo los temas ambientales, sociales, económicos deben estar arti culados en la organización y/o actualización de una regulación, para garantizar el comercio justo y la seguridad alimentaria y nutricional.

16 de noviembre – Nuevos (y no tan nuevos) patógenos en alimentos ¿cómo hacer que nues tros sistemas de gestión sean más resilientes?. La aparición y reemergencia de patógenos alimen tarios es una preocupación constante para los sis temas de vigilancia de salud pública y la industria alimentaria. Varios factores contribuyen a su apari ción donde se incluyen: cambios en el comporta miento (adaptaciones) de los microorganismos y los consumidores, cambios en las prácticas agríco las y pecuarias, la globalización, la complejidad de las cadenas logísticas, así como la presión selectiva generada por el uso de antimicrobianos. Por otro lado, el avance en las técnicas de diagnóstico ha permitido reconocer nuevos patógenos alimenta rios y detectar a patógenos conocidos en produc tos donde son poco comunes, por lo tanto, enten der la dinámica de estos organismos es necesario
para poder controlarlos en la cadena alimentaria. Latinoamérica no es ajena a esta situación, que se torna más compleja después de la pandemia de COVID 19 e introduce una variable más al sistema global alimentario.
17 de noviembre - Vegetales saludables: un reto de inocuidad El objetivo de esta mesa temática es mostrar algunos de los avances en la producción y procesamiento de vegetales frescos y mínimamente procesados (lavados, cortados, mezclados), orienta dos a la detección, control, y gestión del riesgo de patógenos como STEC, Salmonella spp. y Listeria monocytogenes en estos productos.
17 de noviembre - Food integrity. La evolución natural en la gestión de la inocuidad. El objetivo de esta sala es presentar un enfoque integral que contribuya a garantizar confianza y que además el sistema alimentario sea transparente y sostenible a través de vigilancia (monitoreo y verificación) y análisis de información (DATA), y que conduzca a una identificación de prioridades en los diferentes eslabones de la cadena y agregar valor a la econo mía agroalimentaria ofreciendo autenticidad, transparencia, inocuidad alimentaria y garantía de calidad.
18 de noviembre - La pandemia silenciosa: el sur gimiento y la propagación de la resistencia a los antimicrobianos en los sistemas alimentarios latinoamericanos. El objetivo de la mesa es presen tar avances desde la perspectiva de los gobiernos y las agencias presentes en LATAM sobre la detección de la RAM en patógenos alimentarios y nuevas acciones. Se cubrirán algunos avances en los requi sitos regulatorios para abordar el potencial de des arrollo de RAM, sus consecuencias para la salud y el medio ambiente.
16 de noviembre - Lo valioso de la data en los sis temas alimentarios. S El objetivo de esta mesa es entender cómo conjuntos de datos de diversas fuen tes con características compartidas pueden usarse en entornos alimentarios complejos para proponer soluciones a problemas como anomalías en las cadenas de suministro, brotes de enfermedades emergentes, demanda de alimentos “limpios”, tra zabilidad epidemiológica y cambio climático, entre otros. Se abordarán temas relacionados con “Big Data”, inteligencia artificial, aprendizaje automático (machine learning), simulación y modelación en sis temas alimentarios, así como los desafíos para su
aplicación en la evaluación y monitoreo de los ries gos de inocuidad de los alimentos.
18 de noviembre - Sistemas alimentarios frente al cambio climático: entre las políticas y las acciones. El cambio climático es una realidad que cada año impacta más la producción y disponibili dad de alimentos. Se estima que la seguridad ali mentaria es una de las amenazas más importantes relacionadas con el cambio climático para la salud humana en todo el planeta. A pesar de la importan cia, este problema ha recibido poca atención, en relación con otros indicadores de salud, indepen dientemente que “acción por el clima” es una de los Objetivos de Desarrollo Sostenible. El efecto del cambio climático no será uniforme en los sistemas alimentarios de la región de Latinoamérica y el Caribe, en particular en los países de ingresos bajos y medianos. Por lo anterior, es conveniente un tra bajo mancomunado para prevenir, detectar y ges tionar los riesgos de transmisión alimentaria asocia dos al cambio climático.
https://www.upb.edu.co/es/congreso-latinoameri cano-alimentos-clamisa



Demanda global de maquinaria para alimentos: foco en la economía circular, la gestión de recursos, las tecnologías digitales y la seguridad de los productos
A pesar de las difíciles condiciones generales, la demanda internacional de maquinarias y equipamiento para la producción, procesamiento y envasado de alimentos y bebidas está en alza. Luego de que a consecuencia de la pandemia cayera a 41.000 millones de euros en 2020 -una reducción del 7%- el comercio internacional de maquinaria para alimentos se recuperó en 2021. Según datos preliminares, ascendió a 44.000 millones de euros -un aumento del 6% con respecto al año anterior- y así volvió a alcanzar los niveles previos a la crisis. Alemania e Italia lideran el mercado mundial en este campo. La feria interpack, que tendrá lugar en Düsseldorf del 4 al 10 de mayo de 2023, ofrecerá mucha información sobre este tema y muchos más en un espacio de diálogo entre fabricantes de maquinaria y clientes de distintas industrias.
Los fabricantes de maquinaria para el procesamien to y envasado de alimentos de Alemania son los líderes mundiales, con una participación del 21% en el comercio internacional en 2021. Las exportacio nes alemanas, que ascendieron a 9.000 millones de euros, aumentaron casi un 5% en 2021. Italia ocupó
el segundo lugar, con exportaciones por 8.900 millo nes de euros, un 8% más que la cifra alcanzada el año anterior. Los siguen a una distancia considera ble China, Países Bajos, Estados Unidos, Suiza, Francia, Japón, España y Canadá. Todos estos importantes países proveedores de maquinaria y
otros más presentarán sus innovadoras soluciones en interpack 2023. El 43% de la maquinaria exporta da en todo el mundo tuvo a Europa como destino. Las principales regiones en ventas fueron Asia y América del Norte, ambas con un 19% de las exporta ciones, seguidas por América Latina, con un 7%; África, con un 6%; Medio Oriente, con un 4%; y, final mente, Australia/Oceanía, con un 2%.

El crecimiento poblacional, el aumento de la urbani zación y una mayor prosperidad continúan impulsan do la demanda de alimentos envasados. La industria enfrenta importantes desafíos: una competencia des piadada y una gran batalla por los mercados y los consumidores. Los altos costos de la energía y los fluctuantes precios de las materias primas afectan los costos de producción y ejercen presión sobre los már genes. Asimismo, la exigencia de producir de manera sostenible es cada vez mayor. Producir bienes de cali dad, incrementar la productividad y, al mismo tiem po, reducir los costos y producir de manera sosteni ble implica una compleja tensión. De cara al futuro, el
éxito y la viabilidad dependerán básicamente de la capacidad para dominar estos desafíos con creativi dad y eficiencia. Y estos desafíos pueden abordarse mediante la tecnología y la digitalización.
La economía circular y la gestión de recursos son temas prioritarios para la industria global del enva sado y de los alimentos. El objetivo consiste en no descartar como desechos los diversos materiales al final de su vida útil o productiva sino reutilizarlos a través de procesos inteligentes. De esta forma es posible ahorrar energía y preservar tanto los recur sos como el ambiente. Uno de los abordajes consis te en utilizar menos material en el envasado y el empaque. Gracias a materiales de menor grosor, películas más delgadas, formatos optimizados y nuevas técnicas de procesamiento, los envases son cada vez más livianos y conservan los mismos nive les -o los superan- de desempeño y estabilidad. Otro elemento clave de la economía circular son los enva ses que se pueden reciclar fácilmente. Los envases plásticos producidos con un solo material se pueden clasificar y reingresar al ciclo más fácilmente.
LALas tecnologías digitales y el uso de datos son dos factores importantes para las industrias de los ali mentos y del envasado. Ofrecen nuevas oportunida des para diseñar la producción, generar datos para optimizar los procesos y hacer un seguimiento del negocio en tiempo real. Contribuyen a aumentar la eficiencia de las plantas, optimizar el uso de los recur sos y flexibilizar aún más el uso de la maquinaria. Las tecnologías digitales permiten reducir los costos de producción, mantenimiento y reparaciones.

Los datos son el nuevo oro de la actualidad. Sin embargo, por sí mismos no tienen utilidad alguna. Su valor proviene sólo de los algoritmos, que anali zan los datos generados por las máquinas, los siste mas y el personal con el fin de identificar los puntos débiles o el potencial de optimización de los equi pos, sistemas o procesos. La gestión de la calidad y del consumo de energía, la planificación de recur sos, el desarrollo de productos y el servicio también se benefician de los grandes datos (big data). Estos datos desempeñan un papel fundamental en el con cepto de gemelo digital, que se puede utilizar para hacer llegar más rápidamente al mercado produc tos, máquinas y sistemas; para poner máquinas en funcionamiento virtualmente; y para probar con anticipación y en forma virtual los nuevos desarro llos en materia de envasado en la máquina «real».
A fin de producir de manera segura y en condicio nes de higiene adecuadas y de satisfacer las nor
mas y requerimientos internacionales, estrictos en algunos casos, es importante contar con máquinas de diseño higiénico que, por otra parte, se optimi zan en forma continua. La limpieza de máquinas y sistemas de producción libre de residuos es uno de los prerrequisitos básicos para satisfacer los reque rimientos de seguridad e higiene. Los sistemas de limpieza en el lugar están muy en boga, dado que garantizan procesos bien definidos, con tiempos optimizados y con el mínimo consumo de recursos como agua, energía y agentes de limpieza y desin fección. Por otra parte, surgen nuevos desarrollos en este campo para evitar procesos de limpieza exagerados y, a la vez, garantizar la máxima seguri dad.
El envasado inteligente contribuye a reducir el desperdicio de alimentos. Este sistema monitorea los factores ambientales a los que están expuestos los alimentos, los registra y ofrece información sobre el estado de calidad del producto. Las medi das de inspección y control brindan un nivel de seguridad adicional. Los sistemas informáticos de rastreo y seguimiento aseguran la trazabilidad con tinua del producto a lo largo de toda la cadena de valor, brindando así mayor transparencia. También detectan los puntos débiles en la cadena logística. La tecnología en tiempo real brinda información exacta sobre las rutas y el lugar en que se encuen tran los productos e incluso sobre interrupciones en la cadena de frío. De esta forma es posible organizar con mayor eficiencia las rutas comerciales y reducir los costos.



La FAO hace un análisis prospectivo pensando en el futuro de la seguridad alimentaria
Al mismo tiempo que el mundo comienza a comprender la importancia de transformar los sistemas agroalimentarios para que sean más sostenibles y conscientes del medio ambiente, también existe una creciente demanda de los consumidores por productos alimenticios de origen animal (FAO, 2018). La intensificación de la producción animal puede contrastar con los objetivos de sostenibilidad, dando como resultado compensaciones en varios aspectos ambientales, seguridad alimentaria y bienestar animal (FAO, 2020; Henchion et al., 2021; OCDE y FAO, 2021). Las nuevas tecnologías presentan una alternativa potencial: la producción de animales terrestres y acuáticos sin necesidad de cría y matanza a gran escala.
En 1932, Winston Churchill declaró: “Evitaremos el absurdo de criar un pollo entero para comer la pechuga o el ala, criando estas partes por separado en un medio adecuado” (Churchill, 1932). Después de décadas de investigación y desarrollo, la tecnología ha madurado y su idea se ha hecho realidad. La producción puede rea lizarse a través del cultivo in vitro de células animales y luego procesarse en productos cuya composición puede ser equivalente a los alimentos convencionales sin necesidad del animal completo (Kadim et al., 2015; Post, 2014).
Desde los estudios iniciales a principios de la déca da de 2000, las metodologías de producción de alimen tos basadas en células se han caracterizado bien, lo que significa que ahora están listas para pasar de los labo ratorios a las plantas de producción. En 2013 se presen tó al mundo la primera hamburguesa de res generada mediante esta tecnología (Jha, 2013). En diciembre de 2020, una autoridad competente de Singapur aprobó los primeros nuggets de pollo a base de células. A noviembre de 2021, hay al menos 76 empresas que desarrollan productos similares en todo el mundo (Byrne,

2021). Muchos tipos de productos y materias primas, como varios tipos de carne, aves, pescado, produc tos acuáticos, lácteos y huevos, están en proceso de comercialización futura.
Actualmente se utilizan varios términos, ya que aún no existe una terminología armonizada internacional para indicar este tipo de producto alimenticio o el proceso de producción (Ong, Choudhury y Naing, 2020). Por ejemplo, algunas personas llaman a estos análogos carne "cultiva da", "basada en células" o "de cultivo".
La seguridad alimentaria es una de las principales preocupaciones cuando se aplica una nueva tecno logía a la producción de alimentos. Dentro del para digma del análisis de riesgos, el primer paso de la evaluación de la seguridad es la identificación de peligros, que se puede realizar siguiendo los pasos de producción. Para la producción basada en célu las, las metodologías y los pasos pueden variar mucho según la empresa, el producto final deseado, las instalaciones de fabricación y el equipo. Para ilustrar el proceso de identificación de peligros para la inocuidad de los alimentos, en el Cuadro 1 se pre senta una descripción general genérica de los pasos de producción, seguida de un mapa genérico de posibles peligros y preocupaciones (Tabla 1).
Cuadro 1 - Descripción general de la producción genérica de produc tos alimenticios a base de células
1. Selección de células de una fuente animal.
2. Producción: las células seleccionadas en el paso 1 se multiplican en biorreactores; las células pueden estar ancladas a microportadores o a un andamio para organizar los tejidos en una estructura 3D.
Los comercializadores de productos pueden llamarlos carne “libre de ani males”, “limpia” o “libre de sacrificio”. A los efectos del presente escrito, y sin establecer un precedente, se utiliza el término “basado en células”. Algunos pueden identificar toda la tecnología como "agricultura celular" o "cultivo de células". La falta de definiciones claras para estos términos crea la posibilidad de confusión. Las auto ridades nacionales serán más efectivas si la termino logía que utilizan es 1) transparente y representativa de los productos; 2) informativa para el etiquetado de alimentos, comunicando claramente a los consu midores que los productos producidos a través de la nueva tecnología son diferentes de los convenciona les con los que están familiarizados, pero que tam bién pueden contener los mismos alérgenos poten ciales; y 3) no menospreciar ni generar reacciones en los consumidores (Hallman y Hallman, 2020).

a. Preparación celular.
b. Proliferación celular.
c. Diferenciación celular
3. Recolección del producto.
4. Procesamiento de alimentos: los productos cosechados pueden pro cesarse para darles las formas deseadas y/o combinarse con otros ingredientes para su comercialización.
Líneas celulares de origen: las líneas celulares de partida a menudo se obtienen de un animal de elec ción vivo o sacrificado, con posterior aislamiento celular. Una alternativa común es utilizar células madre pluripotentes inducidas (iPSC), células adul tas reprogramadas que pueden diferenciarse en cualquier tipo de células (Takahashi y Yamanaka, 2006). Aunque las iPSC se han estudiado bien en ratones desde su descubrimiento, los protocolos de diferenciación para varias células animales de ganado, como el pollo, siguen siendo difíciles de
Tabla 1 - Un mapa genérico de peligros/preocupaciones potenciales en los procesos de producción de alimentos basados en células
Transmisión de enfermedades Residuos y Insumo Contaminación infecciosas zoonóticas subproductos novel* microbiológica
Selección celular
Producción
Recolección
Procesamiento
* Un insumo novel significa un paso, material, tecnología o técnica adicional que no se ha utilizado en la producción de alimentos convencional (es decir, andamios o propiedades celulares modificadas).
alcanzar (Post et al., 2020). La posibilidad de apari ción de enfermedades infecciosas zoonóticas y enfermedades transmitidas por los alimentos se reduce considerablemente en comparación con la producción ganadera convencional (Treich, 2021), pero se debe tener en cuenta el uso de suero animal en los medios de cultivo, que pueden introducir patógenos, incluidos virus, bacterias, parásitos y priones (Hadi y Brightwell, 2021; Ong et al. 2021). Sin embargo, la detección temprana de infecciones celulares a través de un control cuidadoso puede limitar en gran medida estos peligros. Además, como en cualquier proceso de producción de ali mentos, es fundamental seguir las buenas prácticas de higiene (BPH). La producción a partir de células se puede realizar en un entorno bien controlado sin riesgo de contaminación por heces o fuentes exter nas (Chriki y Hocquette, 2020). Sin embargo, la apli cación de antibióticos durante algunos de los pasos de producción aún puede ser necesaria. En conse cuencia, los residuos pueden permanecer en el pro ducto final como residuos antimicrobianos (Agmas y Adugna, 2018).
Componentes del medio de crecimiento: los medios de cultivo a base de suero animal, especialmente aquellos con suero fetal bovino (FBS), son la opción más común (Hadi y Brightwell, 2021; Post, 2012; Post et al., 2020) y pueden presentar un mayor riesgo de contaminación microbiológica (Chriki y Hocquette, 2020). Dichos peligros pueden gestionarse y contro larse mediante el monitoreo adecuado de patóge nos clave (Specht et al., 2018). Además, ha habido un
esfuerzo sustancial en el desarrollo de medios sin suero animal para superar las preocupaciones rela cionadas con FBS y actualmente hay al menos 100 formulaciones de medios diferentes disponibles (Andreassen et al., 2020).
Superficies de adhesión: para que las células aumenten de tamaño y generen fibras musculares, se unen a estructuras 3D, que estimulan físicamente a las células. Estos andamios pueden ser sintéticos o compuestos de materiales comestibles, estos últi mos pueden ser preferibles ya que no es necesario retirarlos del producto final (Allan, Ellis y De Bank, 2021; Campuzano, Mogilever y Pelling, 2020; MacQueen et al., 2019). La mayoría de los biomate riales utilizados como andamios en la producción de alimentos a base de células no se conoce que causen reacciones alérgicas al consumirlos. Se debe prestar mucha atención para garantizar que no se introduzcan materiales derivados de fuentes cono cidas de alergenicidad. Por ejemplo, la quitina o el quitosano pueden desencadenar respuestas alérgi cas en personas que también son alérgicas a los crustáceos.
Cambios en las propiedades físico-químicas: para obtener un crecimiento celular exponencial y una densidad celular óptima, las líneas celulares inicia les se subcultivan constantemente (Masters y Stacey, 2007). Como en todas las líneas celulares a las que se les permite propagarse a lo largo de muchas generaciones, puede existir el riesgo de que se produzca una deriva genética o epigenética
y esto debe controlarse adecuadamente (Ong et al., 2021).
Crioprotectores: se pueden usar crioprotectores como la inulina y el sorbitol para el almacenamiento celular (Elliot et al., 2017). Se debe tener cuidado de que no se produzca transferencia al producto final en concentraciones que puedan causar un riesgo para los consumidores (MacDonald y Lanier, 1997; Savini et al., 2010).
Contaminación microbiológica durante todo el pro ceso: al igual que con todas las técnicas de fermenta ción y procesamiento de alimentos, la limpieza de las operaciones, el control continuo y el cumplimiento estricto de las buenas prácticas de higiene y de manufactura son fundamentales para evitar la con taminación microbiológica, que puede ocurrir en cualquier paso del proceso de producción. La aplica ción del sistema de análisis de peligros y control de puntos críticos (HACCP) también se considera eficaz.
La FAO, junto con la Organización Mundial de la Salud (OMS), proporcionan asesoramiento científico al Codex Alimentarius -el organismo internacional que establece las normas alimentarias- de acuerdo con los principios y directrices establecidos para la evaluación de riesgos de sustancias individuales, como aditivos químicos, residuos y contaminantes (FAO, 2021a), evaluación de riesgos microbiológicos (FAO, 2021b) y evaluación de la inocuidad de los ali mentos (FAO y OMS, 2011). La caracterización mole cular, el análisis bioquímico/físico, la evaluación de la toxicidad y la alergenicidad y el análisis de la com posición nutricional son los elementos principales de la evaluación genérica de la inocuidad de los ali mentos (FAO y OMS, 2008). Los expertos sugieren que dichos principios y metodologías estandariza dos son aplicables para la evaluación de la inocui dad del producto final de los alimentos basados en células. Todas las evaluaciones de riesgo de los ali mentos se realizan caso por caso, y aún no ha habi do un consenso sobre en qué casos los productos alimenticios a base de células requieren una evalua ción de riesgos por separado.
Ong et al. (2021) ha enumerado las áreas clave de investigación para mejorar la garantía de inocuidad de los productos alimenticios a base de células y afirman que es importante centrarse en la novedad de los productos. A pesar de las posibles brechas de conocimiento y las incertidumbres que pueden estar presentes, es poco probable que la mayoría de los peligros y preocupaciones identificados sean nuevos, por lo que es clave priorizar cualquier nove dad y diferencia en el proceso y los productos (Ong et al., 2021).
¿Es carne? La tecnología de “cultivo celular” puede utilizar como fuente tanto células vegetales como animales, y también puede conducir a la producción de productos acelulares como leche, proteínas o grasas (Rischer, Szilvay y Oksman-Caldentey, 2020).

Si bien las alternativas a la carne a base de plantas no se clasificarían como carne, aún no está claro si esto también es cierto para los productos alimenti cios a base de células animales. Además, si la carne a base de células se clasifica como carne y/o incluye "carne" en su nombre, puede tener varias implica ciones para las reglamentaciones existentes para el etiquetado y la garantía de seguridad y calidad.
¿Quién debería estar a cargo? El glosario de la Organización Mundial de Sanidad Animal (OIE) esta blece que la carne “significa todas las partes comes tibles de un animal” (OIE, 2021), pero un animal no necesariamente tiene que estar involucrado en la
producción de alimentos a base de células. Por lo tanto, la nomenclatura elegida puede definir quién supervisará a nivel normativo la gestión de los pro ductos alimenticios a base de células. Dependiendo de los marcos regulatorios nacionales y de la catego rización elegida, estos productos pueden estar suje tos a las regulaciones 1) de carne/ganado (u otro sector relacionado con productos básicos), 2) de proteínas alternativas, 3) de nuevos alimentos, 4) de inocuidad de alimentos o 5) de cualquier combina ción de las anteriores.
Si bien se espera un menor uso de la tierra para la producción de alimentos basada en células en com paración con la ganadería convencional, esta com paración no es sencilla, ya que la ganadería tam bién desempeña funciones ambientales importan tes, como mantener el contenido de carbono del suelo y la fertilidad del suelo (Chriki y Hocquette, 2020). Según Mattick (2018), la producción de ali mentos a base de células también puede tener un potencial reducido de eutrofización, similar a la producción avícola convencional, pero menor que la carne de res o cerdo (Tabla 2). La ventaja poten cial de la carne a base de células sobre el ganado en términos de emisiones de gases de efecto inverna dero no está clara. Las emisiones de metano (CH4) son la principal preocupación de los rumiantes, además del dióxido de carbono (CO2) y el óxido nitroso (N2O). Por el contrario, el CO2 es el principal gas de efecto invernadero asociado con la produc ción de alimentos a base de células debido al alto uso de energía fósil. Lynch y Pierrehumbert (2019) concluyeron a través de sus estudios de modelado
que la ganadería puede ser una mejor opción que la producción de carne basada en células debido al alto uso de energía de combustibles fósiles de esta última, suponiendo que se mantienen los patrones actuales de consumo de carne. Mattick et al. (2018) sugirieron que la carne a base de células podría implicar algunas compensaciones, con un alto uso de energía que conduce a impactos de calentamien to global potencialmente mayores que la carne de cerdo o aves, pero menor que la carne de res, al tiempo que conserva posibles ganancias en el uso de la tierra. Smetana et al. (2015) señalaron que entre la carne de células, las diversas alternativas proteicas (de origen vegetal, micoproteico, lácteo) y la carne de pollo, la carne a base de células tenía el mayor impacto ambiental debido a sus altos reque rimientos energéticos, pero tenía un menor uso de la tierra y menor potencial de eutrofización. Esto puede llevar a las autoridades nacionales a conside rar la necesidad de una evaluación y seguimiento del impacto ambiental general, además de la nece sidad de garantía de la inocuidad
Los alimentos a base de células deben producirse en interiores sin verse afectados por condiciones climá ticas extremas; por lo tanto, algunos desarrolladores afirman que esto puede contribuir a la seguridad ali mentaria. Además, los productos derivados de ani males (carne, pollo, lácteos, huevos, pescado y pro ductos alimenticios acuáticos) son una fuente importante de proteínas. Buscar formas más eficien tes de producir tales proteínas puede ayudar a garantizar la seguridad nutricional. Algunos presen tan la producción de alimentos a base de células
Tabla 2 – Comparación del impacto ambiental estimado de producir 1 kg de carne (convencional vs basada en células) en los EE.UU.
Categoría de Carne bovina Carne porcina Carne aviar Carne basada impacto en células
Uso de la tierra m2/año 92-113 15,8-18,3 9,5 5,5 (2-8)
Energía (Mi) 78,6-92,6 16,0-19,6 26,6 106 (50-359)
Emisiones GEI (kg CO2-eq.) 30,5-33,3 4,1-5,0 2,3 7 (4-25)
Fuente: Adaptado de Mattick, 2018
como una opción para aquellos que quieren actuar de manera responsable sin alterar sus dietas y normas culturales (Chikri y Hocquette, 2020; Shapiro, 2018). Además, se sugiere que algunos países pueden encontrar atractiva la tecnología para hacer que su suministro de alimen tos sea más autosuficiente a través de la producción basada en células, sin tener que expandir e intensificar su producción ganadera y/o acuícola actual.
Algunos impulsores apoyan la importan cia de esta tecnología con la afirmación de que mejorará drásticamente el bienestar animal (Bhat, Kumar y Fayaz, 2015), ya que se espera que la cantidad total de ganado criado y sacrificado se reduzca en forma significativa (Schaefer y Savulescu, 2014). Sin embargo, dado que el primer paso suele ser realizar biopsias en los animales para recolectar las células, es posible que algunos todavía tengan preocupaciones sobre los problemas de bienestar animal, ya que algunos animales aún tendrían que criarse (Alvaro, 2019) y potencialmente sacrificarse.
Desde la perspectiva de la pérdida de alimentos, la utilización de reses ha sido un problema desafiante en la ganadería convencional. Hay empresas -como los fabricantes de gelatina, alimentos para masco tas y alimentos para peces- que utilizan subproduc tos del ganado y, por lo tanto, ayudan a reducir la pérdida de alimentos. La producción de carne a par tir de células puede contribuir en gran medida a resolver los problemas relacionados con la utiliza ción de canales (Stephens et al., 2018). Sin embargo, no se han explorado los impactos ambientales que pueden ocurrir si otros productos de la ganadería, como el cuero y la lana, se producen por separado y los impactos económicos en dichas industrias (Mattick, Landis y Allenby, 2015).

Si bien la producción de alimentos acuáticos a partir de células puede abrir la puerta a países con pocos
recursos acuáticos, este sector específico tiene una consideración adicional relacionada con la termino logía. Los productos de la acuicultura generalmente se denominan pescados/mariscos “criados” o “culti vados” para distinguirlos de las capturas silvestres. Por lo tanto, los términos utilizados para la produc ción a base de células pueden necesitar palabras diferentes para diferenciarlos claramente los pro ductos de la acuicultura (Hallman y Hallman, 2020).
Como la tecnología requiere una cantidad mucho menor de animales que la ganadería convencional, los productos alimenticios a base de células pueden ser atractivos para quienes siguen un estilo de vida vegetariano o vegano. Cualquier problema ético que surja con respecto a esta producción necesitará la debida consideración. Además, se pueden hacer preguntas sobre si dichos productos pueden consi derarse Kosher, Halal, etc., de acuerdo con las res pectivas religiones, valores y/o tradiciones (Hamdan et al., 2018; Krautwirth, 2018).
No todos los consumidores necesariamente cono cen la ciencia detrás de la producción de alimentos a base de células, y la terminología eventualmente afectará el significado y las connotaciones atribui das a los productos alimenticios así producidos (Bryant y Barnett, 2019; Byrant et al. , 2019).
Aprendiendo de la producción de alimentos impul sada por la tecnología en el pasado, es muy impor
tante que las autoridades comprendan las percep ciones de los consumidores en el contexto local y comiencen un diálogo inclusivo y transparente con ellos en la etapa más temprana posible (Nucci y Hallman, 2015).
La primera hamburguesa de carne de res a base de células se creó a un costo de U$S 375.000 en 2013 (Kupferschmidt, 2013) y el primer nugget de pollo a base de células a U$S 50 en 2019 (Corbyn, 2020). Los costos de producción de la carne a base de células han disminuido, pero siguen siendo caros para la venta al por menor a gran escala. Actualmente, los medios de crecimiento representan la mayor parte de los costos totales de producción (Choudhury, Tseng y Swartz, 2020; Swartz, 2021). Además, la sus titución de la energía basada en combustibles fósiles por fuentes de energía renovables, el mantenimien to de un suministro adecuado de oxígeno, el trata miento de aguas residuales, el transporte hacia todo el mundo y los gastos de mano de obra también pue den aumentar el costo del producto final (Mattick, 2018; Risner et al., 2020). Sin embargo, los productos alimenticios a base de células tienen el potencial de venderse a U$S 5,66 por kg para 2030, que es más
barato que algunas de las carnes convencionales actualmente en el mercado (Swartz, 2021).

Si los productos alimenticios a base de células entran en una categoría que requiere evaluaciones de ino cuidad de acuerdo con los marcos normativos exis tentes, es responsabilidad de las autoridades compe tentes establecer los procedimientos para tales eva luaciones. Asimismo, si los consumidores exigen un etiquetado especial, es responsabilidad de las autori dades pertinentes establecer una política clara. El etiquetado no suele ser un tema sencillo de gestio nar, ya que casi siempre requiere la cuantificación de los ingredientes/productos. Por lo tanto, en este caso, la política deberá establecer un umbral de la cantidad de alimento que se ha producido mediante técnicas basadas en células con fines de etiquetado.
Siempre es importante considerar el caso de apro baciones regulatorias asincrónicas. Es posible que algunos países ni siquiera requieran aprobaciones y que algunos con capacidades técnicas limitadas pueden tener dificultades para establecer el proceso de aprobación. Sin embargo, la realidad es que una vez que un producto alimenticio a base de células ha sido aprobado en un país, es sólo cuestión de tiempo para que viaje a otro país donde los marcos regula torios pueden ser diferentes. Por esta razón, es importante tener diálogos globales inclusivos en una etapa temprana para que el intercambio de información y experiencias pueda beneficiar a muchos países de bajos y medianos ingresos (LMIC).
La FAO ha iniciado varias iniciativas para brindar asesoramiento científico sobre las consideraciones de seguridad alimentaria de los productos alimenti cios a base de células.
Como ya se explicó, la mayoría de los peligros poten ciales en esta tecnología no son nuevos. Por lo tanto, es importante aprender de experiencias pasadas y considerar la aplicación efectiva del paradigma del análisis de riesgos (Ong et al., 2021). Al adoptar varias
metodologías de valoración/evaluación de la seguri dad establecidas en una variedad de campos disci plinarios (como los productos farmacéuticos y las biotecnologías alimentarias, incluidas las tecnologí as convencionales y modernas), se pueden identifi car en forma sistemática varios peligros y se pueden realizar las evaluaciones de seguridad pertinentes de manera adecuada. También hay muchas herramien tas de mitigación de riesgos disponibles en el área de la inocuidad de los alimentos, como buenas prácti cas (BPH, BPM, BPCC) y HACCP y principios y meto dologías generales para la evaluación de la inocui dad de los alimentos completos (FAO y OMS, 2009). Si bien existen muchas herramientas que pueden ser útiles para la evaluación de la seguridad, es posible que se requieran pasos adicionales para algunos procesos o productos particularmente novedosos. Por lo tanto, con los productos alimenticios a base de células, es importante centrarse en las diferencias significativas con los alimentos existentes para que se puedan establecer metodologías efectivas para evaluar la inocuidad de todos los elementos.
Muchos países aún no han experimentado la necesidad de realizar evaluaciones de inocuidad de los productos alimenticios a base de células. Sin embargo, la preparación es clave y es importante que las autoridades competentes inicien diálogos con diversas partes interesadas, incluidos los consu midores, el sector privado, la sociedad civil, las agencias asociadas y los responsables políticos. Los
expertos han enfatizado la importancia de asegurar la inclusión y la transparencia, mientras se preparan para las acciones regulatorias necesarias (FAO y OMS, 2016). Para los países de ingresos bajos y medios, también es importante iniciar la evaluación de la capacidad técnica para garantizar la inocuidad de estos productos, ya que pueden beneficiarse de diálogos con otros países y organizaciones interna cionales para aprender de sus experiencias y obte ner asistencia técnica. Se recomienda participar en los debates globales relevantes para todos los paí ses, ya que la información y los datos compartidos sólo pueden contribuir al bien global, sin la duplica ción de esfuerzos.
La seguridad alimentaria es una responsabilidad conjunta. Las comunicaciones activas y transparen tes a través de la colaboración pública y privada son cruciales, no sólo para preparar mejor a las indus trias y los gobiernos, sino también para maximizar la eficacia de sus programas de inocuidad. Las directri ces claras de inocuidad de alimentos de las autori dades para el sector privado promoverán el enfoque de "seguridad desde el diseño" para garantizar la seguridad alimentaria de la producción de alimen tos basada en células.
FAO. 2022. Thinking about the future of food safety - A foresight report. Rome. https://doi.org/10.4060/cb8667en


Organización para la Alimentación y la Agricultura de las Naciones Unidas. Roma, 2022
Es innegable que las actividades humanas han tenido una influencia significativa en el cambio climático. Esto ha llevado a cambios generalizados en la atmósfera, el océano, la biósfera y la criósfera. Algunos de estos cambios no sólo están ocurriendo a una escala sin precedentes, sino que también se espera que sean irreversibles durante siglos o milenios, especialmente en términos de los impactos en el océano, el aumento global del nivel del mar y el derretimiento de las capas de hielo (IPCC, 2021). Se sugiere que el calentamiento global ha afectado al 80% de la superficie terrestre del mundo, donde reside aproximadamente el 85% de la población mundial (Callaghan et al., 2021).
Sobre la base de planes nacionales de acción climática (o contribuciones a nivel nacional) presentados por varios países, se espera que el calentamiento global supere más de 2,7 °C para finales de siglo (IPCC, 2021; UNEP, 2021; UNFCCC, 2021). Limitar el calentamiento
global inducido por el hombre requiere fuertes reduc ciones en las emisiones de GEI. El Sexto Informe de Evaluación del IPCC (2021) sugiere que cumplir con el objetivo del Acuerdo de París de limitar el calenta miento global a 1,5 °C será extremadamente difícil a menos que se tomen medidas de gran alcance para descarbonizar la economía global (IPCC, 2021). Uno de los desarrollos clave en la reciente cumbre de las Conferencias de las Partes (COP26) fue un compromiso histórico para frenar las emisiones de metano, el Compromiso Global de Metano, que fue firmado por 103 países (ONU Cambio Climático, 2021a). Este gas es considerado 80 veces más poderoso que el dióxido de carbono para atrapar calor en la atmósfera terrestre (Nature, 2021). En la actualidad, con temperaturas glo bales 1,2 °C más cálidas que las temperaturas prein dustriales, el cambio climático ya está exacerbando una serie de eventos extremos (olas de calor, sequías, incendios forestales, huracanes e inundaciones) en diferentes partes del mundo, causando pérdidas sin precedentes en los ecosistemas, economías y vidas.
Los eventos extremos atribuidos al cambio climáti co son cada vez más frecuentes, severos e imprede cibles. Dichos eventos no sólo afectan la seguridad
alimentaria al afectar la producción y el rendimien to agrícola y al interrumpir las cadenas de suminis tro, sino que también afectan la inocuidad alimen taria. Temperaturas elevadas, alternancia de perío dos de sequía severa y lluvias torrenciales, degra dación de la calidad del suelo, aumento del nivel del mar y del océano, la acidificación, entre otros, tienen serias implicaciones sobre varios contami nantes biológicos y químicos en los alimentos al alterar su virulencia, ocurrencia y distribución. Esto aumenta nuestro riesgo de exposición a los peligros transmitidos por los alimentos. Además, la rápida globalización de las cadenas de suministro facilita la amplificación de estos peligros a lo largo del camino, brindando oportunidades para que los incidentes locales se conviertan en brotes interna cionales. Los alimentos inseguros no son aptos para el consumo. Dado que los alimentos suficien tes, asequibles, nutritivos e inocuos se consideran los componentes clave de la seguridad alimentaria, los impactos del cambio climático obstaculizarán nuestros esfuerzos para lograr la seguridad alimen taria frente a una población mundial en aumento y una demanda cada vez mayor de alimentos.

“El cambio de clima (temperaturas globales, pre cipitaciones, patrones de viento y otras medidas del clima) que se atribuye directa o indirectamen te a la actividad humana que altera la composi ción de la atmósfera global y que se suma a la variabilidad climática natural observada durante períodos de tiempo comparables”
Convención Marco de las Naciones Unidas sobre el Cambio Climático (UNFCCC), 1992.
Según las estimaciones, alrededor del 14% de los alimentos producidos se pierden durante la etapa de producción antes de que lleguen al nivel minoris ta o a los consumidores. Parte de esta enorme pérdi da se debe a varios problemas de contaminación (FAO, 2019) y el cambio climático puede exacerbar la pérdida al generar condiciones propicias para la ocurrencia y diseminación de peligros transmitidos por los alimentos.
En 2008, la FAO publicó un informe pionero titu lado “Cambio Climático: Implicaciones para la
LA ALIMENTACIÓN LATINOAMERICANAInocuidad de los Alimentos”, que proporcionaba una visión general amplia de los diversos efectos del cambio climático en el panorama de la inocuidad. Posteriormente, en reconocimiento del creciente cuerpo de evidencia científica que vincula el cambio climático con los diversos peligros que pueden entrar en la cadena alimentaria, la FAO publicó en 2020 “Cambio Climático: Revelando la Carga Sobre la Seguridad Alimentaria”. Sobre la base de ambas publicaciones, a continuación se describen breve mente los impactos del cambio climático sobre algu nos peligros transmitidos por los alimentos (micro organismos patógenos, floraciones de algas y mico toxinas).
Los cambios en las temperaturas y las precipita ciones están afectando la distribución geográfica y la persistencia de los patógenos transmitidos por los alimentos. La mayor incidencia de infecciones por varios patógenos como Salmonella spp. y Campylobacter spp. en diferentes partes del mundo puede estar relacionada con el aumento de las tem peraturas (Kuhn et al., 2020; Lake, 2017).
La evidencia reciente apunta a una posible aso ciación entre el aumento de las temperaturas y el
aumento de las tasas de resistencia a los antimicro bianos en patógenos humanos (Escherichia coli, Klebsiella pneumoniae y Staphylococcus aureus ) (MacFadden et al., 2018; McGough et al., 2020). En una tendencia preocupante, varios patógenos trans mitidos por los alimentos y el agua: Vibrio cholerae, Campylobacter spp., Listeria monocytogenes , Salmonella spp, Escherichia coli y Arcobacter sp. muestran cada vez más resistencia a los antibióticos clínicamente importantes, lo que subraya la impor tancia de controlar este problema (Dengo-Baloi et al., 2017; Elmali y Can, 2017; Henderson et al., 2017; Olaimat et al., 2018; Poirel et al., 2018; Van Puyvelde et al., 2019; Wang et al., 2014; Wang et al., 2019).
El aumento en la frecuencia y duración de la pro liferación de algas nocivas a lo largo de las costas y en los lagos de todo el mundo puede atribuirse a una combinación de eutrofización, precipitaciones intensas, temperaturas más cálidas y acidificación de los océanos, entre otros factores. Si bien las algas son un componente natural del ecosistema acuáti co, las floraciones de algas pueden bloquear la luz solar de otras plantas y animales marinos. Cuando las algas mueren, el proceso de descomposición puede causar zonas “muertas” o hipóxicas que no pueden albergar vida acuática. Ciertas especies de algas también producen toxinas que pueden bioacu mularse en pescados y mariscos e inducir síndromes tóxicos en humanos cuando se consumen. Entre otras, la intoxicación por ciguatera es causada por ciguatoxinas, que son producidas por dinoflagela dos de los géneros Gambierdiscus y Fukuyoa. La into xicación por ciguatera es un importante problema de transmisión alimentaria en la región del Pacífico, que afecta a toda la cadena alimentaria acuática (FAO y OMS, 2020).
Las micotoxinas son metabolitos tóxicos produ cidos por diversos hongos que contaminan los culti vos básicos y comerciales (maíz, arroz, maní, sorgo, etc.). Los factores (temperatura, humedad relativa y daños en los cultivos por plagas) que influyen tanto en la susceptibilidad de las plantas a las infecciones fúngicas como en la producción de micotoxinas se ven afectados por el cambio climático. Dado que las zonas templadas más frías se vuelven más cálidas y

más propicias para la agricultura, se están abriendo nuevos hábitats para las plagas agrícolas y las espe cies de hongos tóxicos. Por ejemplo, las aflatoxinas, que tradicionalmente se consideraban un problema en áreas tropicales (como en algunas partes de África), ahora están bastante establecidas en otras zonas geográficas y regiones (como en el Mediterráneo) (Chhaya, O'Brien y Cummins, 2021).
Las prácticas poscosecha inadecuadas para el seca do, el almacenamiento y el transporte pueden exa cerbar el riesgo de exposición a micotoxinas, como las aflatoxinas y la ocratoxina A.

En el caso de algunos de estos peligros transmiti dos por los alimentos, como las micotoxinas y las toxinas de las algas, hay una incidencia creciente en áreas sin antecedentes de estas enfermedades. Esto pone a las áreas afectadas en desventaja, ya que puede haber sistemas de vigilancia y medidas de manejo insuficientes para detectar y manejar los brotes, poniendo así en riesgo la salud pública. Además, las enfermedades transmitidas por los ali mentos generalmente no se notifican, lo que dificul ta estimar su verdadera carga.
Es importante garantizar que las cadenas de sumi nistro de alimentos y los sistemas regulatorios estén
mejor preparados para adaptarse a los crecientes impactos del cambio climático en la inocuidad ali mentaria. Los sistemas de alerta temprana generali zados y las medidas sólidas de seguimiento y vigi lancia son elementos importantes para prevenir y controlar los brotes de enfermedades transmitidas por los alimentos, especialmente en los países más vulnerables al clima. El éxito de estos sistemas depende en última instancia de la difusión efectiva de información y la transparencia en el intercambio de datos con todos los actores relevantes. Sin embargo, la efectividad de dichos sistemas depende en gran medida de las capacidades para recopilar y analizar información sobre los impactos climáticos. Actualmente hay investigaciones inadecuadas sobre los impactos climáticos en áreas que pueden sopor tar la mayor parte de los mismos (Callaghan et al.,

2021). Esta “brecha de atribución” deberá abordarse aumentando la capacidad y el financiamiento para la investigación en los países más vulnerables al clima.
La integración de sistemas de previsión estructu rados permitiría un enfoque más prospectivo de la inocuidad de los alimentos que complementaría las medidas de seguimiento y vigilancia. Los enfoques prospectivos ayudarían a identificar y abordar las preocupaciones emergentes sobre inocuidad de los alimentos exacerbadas por el cambio climático. Se necesitará un enfoque proactivo en lugar de una res puesta reactiva a los impactos climáticos. Junto con la preparación, la trazabilidad a lo largo de las cade nas de suministro, facilitada por las innovaciones digitales, desempeñará un papel importante para mantener la inocuidad al rastrear y eliminar los pro ductos alimenticios contaminados antes de que se conviertan en un problema de salud pública. Dado que los impactos del cambio climático en la ino cuidad alimentaria mundial son multidisciplinarios por naturaleza, esto implica una respuesta unificada a los crecientes desafíos y se necesita un enfoque inte grado e intersectorial. Un mayor compromiso entre los esfuerzos locales, nacionales y globales que aprove chan la experiencia y los recursos en múltiples secto res del medio ambiente, la agricultura y la salud -en otras palabras, un enfoque de One Health para los pro blemas de seguridad alimentaria- deberá ser la norma frente al cambio climático. La transformación de los sistemas agroalimentarios requerirá un mayor énfasis en las conexiones entre las diversas disciplinas, lo que incluye la inocuidad de los alimentos, frente a una
amenaza existencial como el cambio climático, como se reiteró en la Cumbre de Sistemas Alimentarios de las Naciones Unidas de septiembre de 2021 (https://www.un.org/en/food-systems-summit).
Callaghan, M., Schleussner, C., Nath, S., Lejeune, Q., Knutson, T.R., Reichstein, M., Hansen, G. et al. 2021. Machine-learning-based evidence and attribution mapping of 100,000 climate impact studies. Nature Climate Change, 11(11): 966–972. https://doi. org/10.1038/s41558-021-01168-6
Chersich, M.F., Scorgie, F., Rees, H. & Wright, C.Y. 2018. How climate change can fuel listeriosis outbreaks in South Africa. South African Medical Journal, 108(6):453–454. Chhaya, R.S., O’Brien, J. & Cummins, E. 2021. Feed to fork risk assessment of mycotoxins under climate change influen ces - recent developments. Trends in Food Science & Technology: S0924224421004842 . https://doi.org/10.1016/j.tifs.2021.07.040
Dengo-Baloi, L.C., Sema-Baltazar, C.A., Manhique, L.V., Chitio, J.E., Inguane, D.L. & Langa, J.P. 2017. Antibiotics resistance in El Tor Vibrio cholerae 01 isolated during cholera outbreaks in Mozambique from 2012 to 2015. PLoS One, 12(8): e0181496. Cited 15 November 2019. https://doi.org/10.1371/journal. pone.0181496
Elmali, M. & Can, H.Y. 2017. Occurrence and antimicrobial resistance of Arcobacter species in food and slaughterhouse samples. Food Science and Technology, 37(2): 280–285. ttps://doi.org/10.1590/1678-457X.19516
FAO. 2008. Climate change: Implications for food safety. Rome. http://www.fao.org/3/i0195e/i0195e00.pdf

FAO. 2019. The State of Food and Agriculture. Moving forward on food loss and waste reduction. Rome. https://www.fao.org/3/ca6030en/ca6030en.pdf
FAO. 2020. Climate change: Unpacking the burden on food safety. Food safety and quality series No. 8. Rome. https://www.fao.org/3/ca8185en/CA8185EN.pdf
FAO & WHO. 2020. Report of the Expert Meeting on Ciguatera Poisoning. Rome, 19-23 November 2018. Food Safety and Quality series No. 9. Rome. https://doi.org/10.4060/ca8817en
FAO, IFAD, UNICEF, WFP & WHO. 2021. The State of Food Security and Nutrition in the World 2021. Transforming food systems for food security, improved nutrition and affordable healthy diets for all. Rome. https://www.fao. org/3/cb4474en/cb4474en.pdf
He, X. & Sheffield, J. 2020. Lagged compound occurrence of droughts and pluvials globally over the past seven decades. Geophysical Research Letters, 47(14):e2020GL087924. https://doi.org/10.1029/2020GL087924
Henderson, J.C., Herrera, C.M. & Trent, M.S. 2017. AlmG, res ponsible for polymyxin resistance in pandemic Vibrio cholerae, is a glycyltransferase distantly related to lipid A late acyltrans ferases. Journal of Biological Chemistry, 292(51): 21205–21215. IPCC. 2021. Summary for Policymakers. In: V. MassonDelmotte, P. Zhai, A. Pirani, S. L. Connors, C. Pean, S. Berger, N. Caud, Y. Chen, L. Goldfarb, M. I. Gomis, M. Huang, K. Leitzell, E. Lonnoy, J.B.R. Matthews, T. K. Maycock, T. Waterfield, O. Yelekci, R. Yu & B. Zhou, eds. Climate Change
2021: The Physical Science Basis. Contribution of Working Group I to the Sixth Assessment Report of the Intergovernmental Panel on Climate Change, pp. 1–41. Cambridge, UK, Cambridge University Press, In Press. https://www.ipcc.ch/report/ar6/wg1/downloads/report/IPC C_AR6_WGI_Full_Report.pdf
Kuhn, K.G., Nygard, K.M., Guzman-Herrador, B., Sunde, L.S., Rimhanen-Finne, R., Trönnberg, L., Jepsen, M.R. et al. 2020. Campylobacter infections expected to increase due to climate change in Northern Europe. Scientific Reports, 10(1): 13874. https://doi.org/10.1038/s41598-020-70593-y Lake, I.R. 2017. Food-borne disease and climate change in the United Kingdom. Environmental Health, 16(S1): 117. https://doi.org/10.1186/s12940-017-0327-0
MacFadden, D.R., McGough, S.F., Fisman, D., Santillana, M. & Brownstein, J.S. 2018. Antibiotic resistance increases with local temperature. Nature Climate Change, 8(6): 510–514.
McGough, S.F., MacFadden, D.R., Hattab, M.W., Molbak, K. & Santillana, M. 2020. Rates of increase of antibiotic resistan ce and ambient temperature in Europe: a crossnational analy sis of 28 countries between 2000–2016. Eurosurveillance, 25(45): pii=1900414.
https://doi.org/10.2807/1560-7917.ES.2020.25.45.1900414
Nature. 2021. Controlling methane to slow global warmingfast. In: Nature. Cited 6 November 2021.
https://www. nature.com/articles/d41586-021-02287-y
Olaimat, A.N., Al-Holy, M.A., Shahbaz, H.M., Al-Nabulsi, A.A., Abu Ghoush, M.H., Osaili, T.M., Ayyash, M.M. & Holley, R.A. 2018. Emergence of antibiotic resistance in
Listeria monocytogenes isolated from food products: A com prehensive review. Comprehensive Reviews in Food Science and Food Safety, 17(5): 1277–1292.
Pokhrel, Y., Felfelani, F., Satoh, Y., Boulange, J., Burek, P., Gädeke, A., Gerten, D. et al. 2021. Global terrestrial water storage and drought severity under climate change. Nature Climate Change, 11(3): 226–233. https://doi.org/10.1038/s41558-020-00972-w Poirel, L., Madec, J.Y., Lupo, A., Schink, A.K., Kieffer, N., Nordmann, P. & Schwarz, S. 2018. Antimicrobial resistance in Escherichia coli. Microbiology Spectrum, 6(4). doi: 10.1128/ microbiolspec.ARBA-0026-2017
UN Climate Change. 2021a. World leaders kick start accele rated climate action at COP26. Press release. In: United Nations Climate Change. Bonn, Germany. Cited 6 November 2021. Https://unfccc.int/news/world-leaderskick-start-acce lerated-climate-action-at-cop26
UN Climate Change. 2021b. Water at the Heat of Climate Action. In: United Nations Climate Change. Cited 6 November 2021. Bonn, Germany. https://unfccc.int/news/water-at-theheart-of-climate-action UNEP. 2021. Emissions Gap Report 2021: The Heat is On – A world of Climate Promises Not Yet Delivered. In: United Nations Environment Programme. Nairobi. https://www.unep.org/resources/emissions-gap-report-2021 UNFCCC. 2021. Nationally determined contributions under the Paris Agreement. Synthesis report. Conference of the Parties serving as the meeting of the Parties to the Paris Agreement. Third session. 31 October to 12 November 2021. Glasgow. https://unfccc.int/sites/default/files/resource/cma2021_08_a dv_1.pdf
Van Puyvelde, S., Pickard, D., Vandelannoote, K., Heinz, E., Barbe, B., de Block, T., Clare. et al. 2019. An African Salmonella typhimurium ST313 sublineage with extensive drug-resistance and signatures of host adaptation. Nature Communications, 10(1): 4280.
Wang, Z., Zhang, M., Deng, F., Shen, Z., Wu, C., Zhang, J., Zhang, Q. & Shen, J. 2014. Emergence of multidrugresistant Campylobacter species isolates with a horizontally acquired rRNA methylase. Antimicrobial Agents and Chemotherapy, 58(9): 5405–5412.
Wang, X., Biswas, S., Paudyal, N., Pan, H., Li, X., Fang, W. & Yue, M. 2019. Antibiotic resistance in Salmonella typhimu rium isolates recovered from the food chain through national antimicrobial resistance monitoring system between 1996 and 2016. Frontiers in Microbiology, 10: 985.
FAO. 2022. Thinking about the future of food safety –A foresight report. Rome. https://doi.org/10.4060/cb8667en
Anahi E. Tabera1; Nicolás E. Cisneros Basualdo2; Víctor A. Ruiz de Galarreta2; Alejandra Krüger3
1Departamento de Tecnología y Calidad de los Alimentos - Facultad de Ciencias Veterinarias - Universidad Nacional del Centro de la Provincia de Buenos Aires (UNCPBA). Tandil, Buenos Aires, Argentina.
2Centro de Investigaciones y Estudios Ambientales - Facultad de Ciencias Humanas – UNCPBA. Tandil, Buenos Aires, Argentina.
3Centro de Investigación Veterinaria de Tandil (CIVETAN) - Facultad de Ciencias Veterinarias – UNCPBA. Tandil, Buenos Aires, Argentina.
Trabajo extraído de parte de la tesis doctoral de Anahí Tabera, año 2021. atabera@vet.unicen.edu.ar
Gran parte de las industrias lácteas de nuestro país son de pequeña y mediana escala, muchas de ellas con limitada incorporación de tecnología, condicio nes edilicias críticas y escasa capacitación del perso nal en Buenas Prácticas de Manufactura e Higiene. En este trabajo se realizó una evaluación microbioló gica de muestras de ambiente, superficies y manipu ladores en seis queserías del partido de Tandil. A nivel de los equipos y superficies, el 67% de los esta blecimientos presentó valores de bacterias mesófi las viables por encima del esperado. En un caso, se identificaron valores altos de coliformes totales y presencia E. coli en mesadas y en las manos de un operario. Esta evaluación permitió observar que, en mayor medida, los problemas hallados se debieron a la falta de capacitación del personal. Por otra parte, se evidenció el interés de las empresas en aspectos de mejoras y la utilidad de los resultados de los análisis microbiológicos como herramientas en las capacitaciones personalizadas a manipulado res. Ambos aspectos favorecerían la realización de asistencia técnica y capacitación necesarias para este sector de industrias.
Palabras clave: control microbiológico de equipos y ambiente, manipuladores, producción quesera
La industria láctea argentina se localiza en una zona productiva que comprende principalmente las pro vincias de Buenos Aires, Córdoba, Santa Fe y, en menor medida, Entre Ríos, la Pampa y Santiago del Estero, y está conformada por una amplia variedad de establecimientos en cuanto al nivel de produc ción. Algunas características, debilidades y fortale zas del sector fueron identificadas en un relevamien to realizado en estas provincias en el periodo 20162018 por la Dirección Nacional Láctea (DNL), depen diente del Ministerio de Agricultura, Ganadería y Pesca de la Nación (MAGyP, 2019), y en un informe del Observatorio de la Cadena Láctea Argentina (OCLA, 2019). Se registró que la actividad láctea argentina produce alrededor de 10.500 millones de litros de leche por año. La mayor parte de la leche (44%) se destina a la elaboración de quesos, debido a un alto consumo interno (12 kg/hab/año), y la res tante a leche en polvo, leche fluida, yogures, dulce de leche y otros (OCLA, 2019).
Por medio de la estratificación de las industrias según el volumen de litros de leche procesada por día, se identificó que un 62% del total procesa menos de 10.000 L de leche/día. Se ubican en este estrato un 66% de las industrias lácteas en la pro vincia de Buenos Aires. Un alto porcentaje de estas
empresas son de tipo artesanal y no cuentan con tecnología industrial, como es el uso de pasteuriza dores, ya que el proceso de pasteurización se reali za de manera más tradicional en las mismas tinas de elaboración de quesos. En general, tampoco cuentan con buena infraestructura edilicia de las áreas de procesos (un 40% presenta condiciones críticas), ya que generalmente son empresas fami liares que se continúan de generación en genera ción sin grandes modificaciones. En su mayoría no realizan controles de consumo de agua ni trata miento de efluentes y no recuperan el suero. En esta categoría también se observa una mayor propor ción de industrias sin capacitación del personal en Buenas Prácticas de Manufactura (BPM) e Higiene (MAGyP, 2019).
El queso es considerado un producto listo para consumir, ya que después de su elaboración y en algunos casos maduración, no se somete a ningún tratamiento para garantizar seguridad antes de su consumo (Kousta et al., 2010). Por lo tanto, cual quier práctica inadecuada durante su elaboración, distribución y venta representa un riesgo importan te para la salud de los consumidores. Las evaluacio nes han identificado un riesgo microbiológico incre mentado en quesos con alto contenido de hume dad, especialmente en quesos de leche cruda (Choi et al., 2016), sin embargo, la contaminación micro biana puede ocurrir en cualquiera de las diversas clases de quesos que existen: blandos, semiduros, duros; elaborados con leche cruda o pasteurizada.
Los microorganismos pueden provenir de distin tas fuentes, incluyendo la leche cruda, el ambiente, el agua contaminada, los equipos con higiene defi ciente, las manos de operarios que toman contacto con el producto ya elaborado, y otras (Kousta et al., 2010). Por ello, factores durante la producción, como la emanación de vapores que se condensan en los techos, utilización de tinas abiertas manuales, así como incorrectos procesos, falta de capacitación de los operarios, uso de agua no segura, equipa mientos con deficiencias higiénicas, contribuyen a un mayor riesgo de contaminación (Córdoba et al., 2016).
Entre los microorganismos patógenos asociados a Enfermedades Transmitidas por Alimentos (ETA) por consumo de quesos se encuentran: Listeria
monocytogenes, Staphylococcus aureus, Salmonella spp. y Escherichia coli productora de toxina Shiga, como por ejemplo cepas E. coli O157:H7 (Merchán Castellanos et al., 2019).
En particular, S. aureus ha sido asociado con bro tes alimentarios en distintos países y se ha identifi cado en quesos frescos elaborados en condiciones sanitarias deficientes, con el consiguiente riesgo de ser consumido sin tratamiento alguno y producir una intoxicación alimentaria (Ferrín Mendoza et al., 2020; Saltos Solórzano et al., 2018). Diversos estu dios muestran que S. aureus puede acceder a los tanques de leche cruda, probablemente debido a la contaminación de la leche con este microorganismo por excreción directa de las ubres de animales con mastitis estafilocócica, tanto clínica como subclíni ca, o por contaminación fecal. El hombre también interviene como fuente de contaminación a través de sus manos, ya que puede ser portador del mismo (Callonet al., 2008).
Además, se han reportado brotes de infecciones con E. coli productor de toxina Shiga asociados a consumo de quesos (Choi et al., 2016; EFSA BIOHAZ Panel, 2020). Este microorganismo es un patógeno que puede provocar severas enfermedades en humanos. Su principal reservorio es el ganado bovi no, por lo cual la leche y los productos lácteos pue den contaminarse y ser vehículos de infección (EFSA BIOHAZ Panel, 2020). Las personas pueden ser por tadoras ocasionales y generar contaminación durante la manipulación de los alimentos si no se aplican correctas prácticas de higiene personal (Torres, 2010).
La implementación de diversas medidas en los establecimientos elaboradores de productos lácteos, como el uso de agua potable, buenas prácticas de higiene y de manufactura, control sanitario de los animales y correcto tratamiento de efluentes, es importante para disminuir el riesgo de contamina ción del producto final (FAO, 2011; González Cáceres, 2012).
Los objetivos de este trabajo fueron realizar una evaluación microbiológica a través de indicadores de calidad e inocuidad de muestras de ambiente, superficies y manipuladores de plantas elaborado ras de quesos de tipo artesanal, y contribuir a la capacitación del personal.

Recolección de información y toma de muestras Se seleccionaron seis empresas que procesan menos de 10.000 L de leche/día (rango de 1.600 a 9.000 L leche/día) del partido de Tandil y se coordinó una visita a cada establecimiento. En cada caso, pri mero se realizó una inspección visual que compren dió estado de las instalaciones, condiciones de equi pamientos, presencia de cartelería sobre normas de higiene para los operarios, vestimentas de los mis mos (Figuras 1 y 2).


Posteriormente, se efectuó una toma de mues tras en las condiciones en las que se encontraba la fábrica al momento de la visita. Para realizar la eva luación microbiológica ambiental, se colocaron pla cas de Petri, con los medios PCA (PlateCountAgar) e YGC (Chloramphenicol Yeast Glucose Agar), de labo ratorios Britania®, en la sala de elaboración (en dis

tinto número y lugares según el establecimiento) y se expusieron abiertas al aire durante 15 min (Figura 3a). Las placas se transportaron refrigeradas hasta su procesamiento.
También se tomaron muestras por el método de hisopado de mesadas y de equipos (Figura 3b) y de manos de manipuladores (Figura 3c) que estaban elaborando quesos o se encontraban en la sala de afinado de quesos o en el proceso de pintado y eti quetado. Para las muestras de mesadas, delimita das con un marco estéril de 100 cm2, se emplearon hisopos Britania® que ya vienen embebidos en caldo Letheen. Se tomó el hisopo ya humedecido y se pasó por la superficie determinada por una plan tilla, sosteniéndolo en un ángulo de 30º y cubriendo toda el área en diferentes direcciones. Finalmente se colocó el hisopo en un tubo estéril, rotulado y mantenido en refrigeración hasta su posterior análi sis. En el caso de las muestras de los manipuladores, se utilizaron tubos humedecidos con agua estéril o solución fisiológica, empleando uno para cada mano. Se hizo rotar el hisopo en la super ficie de la palma de la mano y luego se pasó en la zona entre los dedos. Ambos hisopos se coloca ron en el mismo tubo con diluyen te y se guardaron con medio de transporte en refrigeración hasta su procesamiento.

Las placas de PCA y de YGC expuestas al ambiente se incubaron 24-48 h a 35°C y 72 h a 30°C, respectiva mente, y se realizaron los correspondientes recuen tos de unidades formadoras de colonias (UFC) de bacterias mesófilas viables y mohos y levaduras (APHA, 2015). Se expresaron los resultados en UFC por el tiempo de exposición y se consideraron acep tables los recuentos < 102 UFC/15 min.
Las muestras de equipos y mesadas obtenidas por hisopados se procesaron para evaluar distintos grupos de indicadores de calidad e inocuidad (Michanie, 2013). Se trabajó con la técnica de siem bra en profundidad: se colocaron los inóculos en las placas de Petri para luego añadir los medios atem perados y homogeneizarlos con el inóculo. Se empleó el medio PCA para recuento de bacterias mesófilas viables y las placas se incubaron 24-48 h a 35°C, Violeta Rojo Bilis agar (VRB) que se incubaron durante 24 h a 30°C para coliformes totales y duran te 24 h a 45°C para coliformes termotolerantes. En caso de ser necesario, se realizaron diluciones suce sivas. El número de colonias obtenidas se multiplicó por el factor de dilución y por el volumen del dilu yente empleado en el muestreo y se expresó como UFC/100 cm2. Se realizaron las pruebas bioquímicas para identificación de E. coli (Da Silva et al.; 2013; Cowan and Steel, 2003). Se determinó un límite de aceptabilidad de 102 UFC/100 cm2 en superficies lim pias para los indicadores de calidad (bacterias mesófilas viables y coliformes totales) y un criterio de ausencia/100 cm2 para el caso de los indicadores de inocuidad (coliformes termotolerantes, E. coli) (Michanie, 2013).
Las muestras de hisopados de manos fueron sembradas en placas que contenían Baird Parker
agar (adicionado de yema de huevo y telurito de potasio), incubadas 48 h a 35°C para la determina ción de S. aureus, y también sembradas en placas con VRB agar e incubadas durante 24 h a 45°C para determinación de E. coli. Se realizaron pruebas bio químicas para confirmación de las colonias obteni das (Da Silva et al.; 2013; Cowan and Steel, 2003). El criterio establecido, debido al riesgo que represen tan, fue ausencia de ambos microorganismos en las manos de los manipuladores.


Se prepararon informes con los resultados y fueron entregados a cada establecimiento. Se realizaron sugerencias en los casos que correspondía. Posteriormente, se elaboró y distribuyó un manual de capacitación en BPM e Higiene para los operarios en el cual se explicaban las pautas a seguir para correcta higienización de manos durante la labor en fábrica, manipulación de la mesada, moldeado de quesos, salado, etc., y comportamiento higiénico adecuado al concurrir al baño en los horarios de trabajo.
En las visitas a los establecimientos se observó que la mayoría contaba con cartelería en zona de ingreso a las salas y en baños, pedaleras o sistemas automáti cos en lavamanos, con expendedor de jabón y alco hol en gel. En general, la vestimenta era correcta, ya que contaban con delantal y botas, aunque en pocos casos barbijo y guantes; sin embargo, en algunos casos se observó deficiente higiene de equipos e ins talaciones inadecuadas, como por ejemplo falta de filtro sanitario y lavamanos y lavabotas al ingresar.
Los resultados de los análisis sobre la carga microbiológica ambiental mostraron valores por

debajo a 102 UFC para bacterias mesófilas viables y mohos y levaduras en el tiempo de exposición deter minado, excepto en el establecimiento número 5 que presentó un recuento mayor de bacterias mesó filas viables (2,7 x 102 UFC/15 min.).
A nivel de los equipos y superficies, el 67% de los establecimientos presentaron valores de bacterias mesófilas viables por encima del esperado, en el rango de 5,0 x 102 a 1,6 x 103 UFC/100 cm2. El valor más alto lo presentó el establecimiento número 3, que también mostró recuentos altos de coliformes totales y colifor mes termotolerantes en las muestras de superficies y presencia de E. coli en superficie y en una muestra de hisopado de manos de un operario. El resto de mues tras de hisopado de manos de los operarios fueron negativas para los microorganismos buscados.
Un alto porcentaje de las industrias lácteas de nues tro país son micropymes y pymes, que llevan a cabo producciones con características particulares que las diferencian de las industrias que elaboran quesos a gran escala. En los casos presentados, se reflejaron las observaciones realizadas a nivel nacional sobre la necesidad de mejora de diversos aspectos higiéni cos y sanitarios. Este trabajo, si bien restringido a un pequeño grupo de industrias y con un muestreo limi tado a determinar las condiciones al momento de la

visita, logró identificar diversos problemas a nivel microbiológico. Asimismo, propició el acercamiento a las fábricas, las que demostraron un marcado inte rés y algunas consultas técnicas. Un ejemplo espe cial de ello fue el caso del establecimiento 3, que presentó graves problemas de contaminación en mesadas y en manos del operario presente, los cua les fueron inmediatamente comunicados y permitió el intercambio con sugerencias de mejoras. La asis tencia técnica y la capacitación se encuentran entre las propuestas de perfeccionamiento para este sec tor, para incrementar rendimientos, calidad higiéni co-sanitaria y diversificación de la producción (MAGyP, 2019). Este trabajo permitió evidenciar la gran utilidad de los resultados de los análisis micro biológicos en las formaciones personalizadas de manipuladores.
1. MAGyP. 2019. Ministerio de Agricultura, Ganadería y Pesca de la Nación. Dirección Nacional Láctea. Estado de situación de la Industria Láctea Argentina para la definición de políticas públi cas 2016-2018.Informe de la Dirección Nacional Láctea. Disponible en: https://www.magyp.gob.ar/sitio/areas/ss_lecheria/industria/est ado/estado.pdf
2. OCLA. Observatorio de la Cadena Láctea Argentina. Informe de coyuntura. 2019; 9:1-25. Disponible en: http://www.ocla.org.ar/contents/news/details/13373360-infor me-de-coyuntura-n009-marzo-2019
3. Kousta M, Mataragas M, Panagiotis S, Drosinos E. 2010. Prevalence and sources of cheese contamination with pathogens at farm and processing levels. Food Control; 21:805-815.
4. Choi K, Lee H, Lee S, Kim S, Yoon Y. 2016. Cheese Microbial Risk Assessments -A Review. Asian-Australasian Journal of Animal Science; 29: 307-314.
5. Córdoba J, Di Giorgi H, Zubiaurre L, Cisneros Basualdo NE,Puricelli M, Rolando R. 2016.Gestión del agua y residuos de queserías familiares del Cluster Quesero de Tandil: Resultados Preliminares. I Jornadas Internacionales y III Nacionales de Ambiente. Tandil.
6. Merchán Castellanos, NA, Pineda Gómez LM, Cárdenas Parra AK, González Neiza NC, Otálora Rodríguez MC, Sánchez Neira Y. 2019. Microorganismos comúnmente reportados como causantes de enfermedades transmitidas por el queso frescos de las Américas, 2007-2016. A Review. Revista Cubana de Higiene y Epidemiología; 56 (1). Disponible en:http://www.revepidemiolo gia.sld.cu/index.php/hie/article/view/171/260
7. Ferrín Mendoza YM, Guevara Muñoz JF, Andrade Lozano JM, Macías Andrade EF, López M. 2020. Evaluación de la presencia de Staphylococcus aureus en queso fresco artesanal del mercado municipal del Cantón Junín de la Provincia de Manabí. Alimentos Hoy. Rev. de la Asociación Colombiana de Ciencia y Tecnología de Alimentos; 28 (49): 41-46.

8. Saltos Solórzano JV, Marquez Bravo YJ, López Apolinario AI, Martínez Abreu J, Guerrero Proaño G. 2018. La implementación de procedimientos estandarizados en la prevención de enferme dades transmitidas por alimentos. Conteo microbiológico de Staphylococcus aureusen quesos frescos. Rev. Médica Electrón5rdica: 40 (2): 371-382.
9. Callon C, Gilbert F, De Cremoux R, Montel M-C. 2008.
Application of variable number of tandem repeat analysis to determine the origin of S. aureus contamination from milk to che ese in goat cheese farms. Food Control; 19: 143-150.
10. EFSA BIOHAZ Panel.KoutsoumanisK, Allende A, AlvarezOrdóñez A,Bover-CidS,ChemalyM, Davies R, et al. 2020. Pathogenicity assessment of Shiga toxin�producing Escherichia coli (STEC) and the public health risk posed by contamination of Food with STEC. EFSA Journal;18(1).
11. Torres AG (ed).2010. Pathogenic Escherichia coli in Latin America. Sharjah: Bentham SciencePublishers Ltd.
12. FAO. Buenas Prácticas de Manufactura en la elaboración de productos lácteos. 2011. Buenas Prácticas en el manejo de la lecheManual 2 de la serie. Disponible en: http://www.fao.org/3/bo953s/bo953s.pdf
13. González Cáceres M. 2012. Aspectos medio ambientales aso ciados a los procesos de la industria láctea. Sitio Argentino de Producción Animal. MundoPecuario;8 (1): 16-32.
14. American Public Health Association (APHA). 2015. Compendium of Methods for the Microbiological Examinations of Foods. 5° Ed. Washington: Salfinger Y, Tortorello, ML (ed)
15. Michanie S. 2013. Monitoreo de higiene de las superficies. Apuntes de Laboratorio. Laboratorios Britania SA.; 2:3-18. Disponible en: www.britanialab.com/capacitacion.
16. Da Silva N, Taniwaki MH, Junqueira V, Silveira N, do Nascimento M, Gomes R. 2013. Microbiological Examination Methods of Food and Water. A Laboratory Manual. CRC Press.
17. Cowan ST, SteelKJ. 2003. Manual for the identification of medical bacteria. 3° Ed. Chambrige University Press.
ALMOND BOARD OF CALIFORNIA CONSEJO DE ALMENDRAS DE CALIFORNIA www.almendras.mx
Almendras saludables para productos deliciosos y nutritivos.
Maipú 1300 - Piso 4 (C1006ACT) Buenos Aires - Argentina Tel.: (54 11) 4314-4100 amg@amg.com.ar / www.amg.com.ar
Elaboramos aditivos para la industria alimentaria. Prémix para fortificación de alimentos, enzimas, levaduras, conservantes biológicos y fibras entre otros. Calidad, conocimiento e inno vación.


Ruta Provincial Nº2 al 3900 (Km 13) (3014) Monte Vera - Santa Fe – Arg. Tel.: (54 342) 490-4600 Líneas rotativas Fax: (54 342) 490-4600 asema@asema.com.ar www.asema.com.ar
Asesoramiento, diseño y fabricación de equipos para la industria alimen taria, transportes sala de despostes y empaque. Tanques sanitarios. Intercambiadores de calor. Tecnología en concentración y secado. Túneles de congelado I.Q.F.
9 de Julio 2189 (1702)
Ciudadela - Bs. A. - Argentina Tel.: (54 11) 4647-1920 / 6009-9696 alimentos@bacigalupo.com.ar www.bacigalupo.com.ar
Fábrica de caramelo líquido natural, colorante caramelo líquido natural. Salsas de frutilla, caramelo, choco late, durazno y maracuyá. Productos elaborados con azúcar de primera calidad. Asesoramiento y
desarrollo de productos en labora torio propio.
Oficina Buenos Aires: Av. Pueyrredón 2488 PB “B” (C1119) CABA – Argentina Tel.: (54 11) 4801-0202
Oficina Villa María: Buenos Aires 365 (5900) Villa María – Córdoba – Arg. Tel.: (54 353) 452-3878 info@biaconsult.com.ar www.biaconsult.com.ar
BIAConsult se especializa en promover soluciones productivas e innovación para la industria de los alimentos y bebidas con los más altos estándares internacionales.

Proveemos equipos unitarios, líneas de proceso, finales de línea, insumos, aditivos e ingredientes, ingeniería para nuevos productos, asistencia técnica y servicio de post venta.
BIOTEC S.A.
Lavalle 1125 Piso 11 (1048) Bs. As. Tel.: (54 11) 4382-8332 biotec@biotecsa.com.ar, www.biotecsa.com.ar Empresa argentina de aditivos alimentarios, elaboración de formulaciones especiales del área de estabilizantes, espesantes y gelificantes. Coberturas para quesos y medios de cultivo a medida de las necesidades de la industria.
BISIGNANO SA
Ruta Provincial 6 km 36.6 (S3013) San Carlos Centro – Santa Fe – Arg. Tel.: (+54 3404) 420129/420982 bisig@bisignano.com.ar www.bisignano.com.ar Máquinas envasadoras para la industria de alimentos.
Termoformadoras. Plantas llave en mano. Equipos de proceso.
Rivadavia 262 L. N. Alem –Misiones - Argentina Tel.: (54 375) 442-0414 WApp: (54 911) 2159-3365 info@bolsasgreen.com www.bolsasgreen.com
Fabricantes de bolsas de friselina ecológicas, reciclables y reutilizables. Bolsas personalizables con logos de empresas. Entregas sin cargo en todo el país.
CERSA CENTRO ENOLÓGICO RIVADAVIA Maza Norte 3237 (5511)
Gutiérrez, Maipú – Mendoza – Arg. Tel: (54 261) 493-2626/2666/ 2502 mendoza@centro-enologico.com www.centroenologico.com.ar Comercialización y distribución en Argentina Latinoamérica de productos químicos para la industria vitivinícola, de conservas, jugueras, de los cítricos y tabacaleras.
DELLA TOFFOLA ARGENTINA Rodriguez Peña 2271 (5511) Zona Industrial Maipú. Mendoza Tel.: +(54 9 261) 509-6808 / 509-6434 info@dellatoffola.com.ar www.dellatoffola.com.ar
Líderes mundiales en tecnologías de procesos para la industria bebible: sectores vitivinícola, cervezas, sidras, bebidas gaseosas, aguas e industria láctea.
Embotellado y envasado - Final de línea - Tratamiento de aguas.
DIVERSEY DE ARGENTINA SA Av. Bernabé Márquez 970 (B1682BAQ) Villa Bosch - Buenos Aires - Argentina Tel.: (+54 11) 7079-4363 consultas@diversey.com https://diversey.com.ar/es-AR Fabricantes de tecnología de
limpieza e higiene profesional para la industria de alimentos y bebidas, y segmento institucional.
San Martin 344, Piso 4 (1004) CABA Tel.: (54 11) 5167-0400 marketing.arg@epson.com.ar www.epson.com.ar
Colorworks, las impresoras Epson creadas para imprimir etiquetas a color a demanda, brindan soluciones de calidad a emprende dores y empresas que buscan satis facer la demanda de etiquetas a color sin depender de terceros, otorgando flexibilidad, productivi dad y eliminando los costos impre vistos. Conoce más de esta línea y sus modelos en: https://epson.com.ar/label-printers
Fructuoso Rivera 2964 1437GRT)
Villa Soldati. Bs. As. - Argentina Tel.: (54 11) 4918-9055/4918-3848 Fax: (54 11) 4918-9055
WApp: (+54 911) 5143-5376 admvtas@fjusto.com.ar www.fabricajusto.com.ar
Elaboración de Colorantes
Caramelo para distintos usos, abas teciendo el mercado de gaseosas, licores, amargos, cervezas, aditivos alimenticios, alimentos para mascotas, panadería, pastelería, café soluble, salsas, caramelos, vinagre, etc., estando en condicio nes de desarrollar y producir a pedi do del cliente el Colorante
Caramelo que requiera. Más de 70 años en la industria alimentaria lo avalan.
FLAIR SRL Int. Lumbreras 1800 (1748) Sector Industrial Planificado General Rodriguez – Bs. As. - Argentina Tel.: (54 237) 485-8850 www.flair.com.ar
Soluciones inteligentes de saborización para la industria alimentaria y farmacéutica. Nuevas tecnologías para nuevos consumido res: proteinas 100% vegetales, reduc ción de sal, azúcar y lactosa.
Lisando de la Torre 958 (S2300DAT) Rafaela - Santa Fe – Arg. Tel.: (54 3492) 43 2174 info@frioraf.com www.frioraf.com
Experiencia, tecnología, servicio y calidad en refrigeración industrial.
GRANOTEC ARGENTINA S.A. Einstein 739 (1619)
Parque Industrial OKS, Garín - Bs. As. - Argentina Tel.: (54 3327) 444415 al 19 granotec@granotec.com.ar; sac@granotec.com.ar; www.granotec.com/argentina Nos especializamos en el desarrollo de soluciones nutricionales, tecnológicas y aplicaciones biotecnológicas para la elaboración de alimentos sanos, funcionales y eficientes, satisfaciendo las nuevas demandas alimenticias de la población y optimizando los proce sos productivos de nuestros clien tes.
Av. Liniers 3205 B1608
Tigre – Bs. As. - Argentina Tel. Bs. As.: (+ 54 11) 5169 – 4700 Sales.argentina@greif.com Tel. Montevideo: (+ 598) 2365-3227 rossana.macias@greif.com www.greif.com
Líder mundial en productos y servicio de envasado industrial. Tambores metálicos y plásticos, bidones de polietileno, Baldes plásticos y botellones de policarbonato.
Hernandarias 1777 (S3016)
Santo Tomé –Santa Fe – Arg. Tel.: (54 342) 474-7000
Buenos Aires: Suipacha 211 7°C (C1008) Tel.: (54 11) 4328-2713 info@hidrobiot.com www.hidrobiot.com
Productos y tecnologías para procesos de separación y tratamientos de aguas. Sistemas de membranas de microfiltración, ultrafiltración, nanofiltracion y ósmosis inversa.
INDUSTRIAS TOMADONI S.A. Alianza 345 CP 1702
Ciudadela - Buenos Aires - Argentina Tel.: (54 11) 4653-3255
Cel.: (+54 911) 5426-5289 tomadoni@tomadoni.com www.tomadoni.com
Industrias Tomadoni S.A participa en servicios de asesoramiento, ingeniería, nuevos proyectos, pro yectos de expansión, moderniza ción y sustitución de equipos de procesos, aumento de capacidad y plantas automatizadas llave en mano.
J.A.CABRERA 3568, 1°PISO (C1186AAP) CABA - ARGENTINA
Tel.: (54 11) 4861-6603
info@ingredients-solutions.com www.ingredients-solutions.com
Soluciones integrales en agentes de batido. Estabilizantes y agentes de textura Tailor Made. Deshidratados naturales. Enzimas, preservantes y antioxidantes naturales. Ingredientes nutricionales. Colorantes naturales. Edulcorantes. Aromas.
José Ingenieros 2475 (B1610ESC)
Bº Ricardo Rojas – Tigre - Arg. Tel.: (54 11) 2150-6670 al 74 comercial@ionics.com.ar www.ionics.com.ar
Ionización gamma de: AlimentosAgronómicos - NutracéuticosFarmacéuticos - CosméticosDispositivos médicos - VeterinariosDomisanitarios.
Pedro Mendoza 1883 (B1686) Hurlingham – Bs. As. – Argentina Tel. y wApp: (54 911) 3199 0590 Skype: leonardo.menconi 115301-5394
ventas@mediglove.com.ar www.mediglove.com.ar Especialistas en guantes descartables de látex, nitrilo, vinilo, polietileno y domésticos.
Av. Roque Sáenz Peña 719 (S2300) Rafaela Santa Fe – Argentina
Tel.: (54 3492) 452191/433162/ 503162 http://www.mercofrio.com.ar Servicio Post Venta, mantenimiento, puesta en servicio, ingeniería y supervisión de obras de equipos frigoríficos
Cnel. Manuel Arias 1639, Piso 5°B
CABA - Argentina
Tel.: (+54 911) 3092-9663 (+54 911) 6051-9508 nutror@nutrorblends.com www.nutrorblends.com www.mcassab.com.ar
Nutror, una marca del Grupo MCassab, desarrolla premezclas nutricionales de vitaminas, minerales, aminoácidos y sustancias bioactivas para la industria de alimentos, bebidas, suplementos alimenticios y nutrición clínica.
LA ROCHE 831 (1708)
MORÓN – BS. AS.- ARG. Tel.: (54 11) 6842-7222 info@serviciosambientales.com.ar www.serviciosambientales.com.ar
Control de plagas, MIP (Manejo Integrado de Plagas), desinsecta ción, desinfección, desratización, ahuyentamiento de aves y murciéla gos. Limpieza de tanques de agua potable. Reporte de visita, Diagrama de planta c/cebaderas, Tratamiento de silos, Trampas de Luz, informes de endencias, Normas HACCP-BPM, auditorías. El Sistemas de gestión de la calidad de SABA ha sido certifica do según las normas ISO 9001:2008.
SIMES S.A. Av. Facundo Zuviría 7259 (3000) Santa Fe - Arg. Tel.: (54 342) 489-1080 / 489-2586 /488-4662 Cel.: (+549 342) 4797 687 ventas@simes-sa.com.ar info@simes-sa.com.ar
Máquinas para la ind alimentaria, farmacéutica, cosmética y química. Homogeneizadores de pistones alta presión. Mezcladores sólidos -líqui dos.
Espora 200 (B1876) Bernal – Bs. As. – Argentina Tel.: 0800-777-5800
contacto@smurfitkappa.com.ar www.smurfitkappa.com.ar www.openthefuture.com.ar
Soluciones sostenibles para un mejor planeta. PAPER – PACKAGINGSOLUTIONS
STAINLESS STEEL MANUFACTURERS S.R.L.
Ministro José Ber Gelbard 338 Parque Industrial Villa María. Villa María – Córdoba – Argentina Tel.: (+549 353) 4018082 ssm@ssm.com.ar - www.ssm.com.ar
Especialistas en el desarrollo y fabricación de Sistemas de Manejo de Polvo, Envasado y Embalaje para la industria alimentaria.
Yerbal 5266 4º Piso (C1407EBN) CABA - Argentina Tel.: (54 11) 4683 -5050 Fax: (54 11) 4683-2020 info@testo.com.ar / www.testo.com.ar
Instrumentos de medición para la verificación y monitoreo de calidad de los alimentos.
Joao.Medeiros@tomra.com www.tomra.com/food
TOMRA Food es una empresa internacional dedicada al diseño y fabricación de sistemas de clasificación para una amplia gama de aplicaciones de alimentos frescos y procesados. Con un enfoque importante en frutos secos, maní, papas, semillas de maíz y girasol, sus soluciones basadas en sensores garantizan calidad y rendimiento excelentes.
URSCHEL LATINOAMÉRICA SRL.
Edison 1205 (2124) Villa Gobernador Gálvez Santa Fe - Argentina Tel. (54 341) 317-1400 mmandel@urschel.com es.urschel.com
Líder mundial en tecnología de corte de alimentos. Desde rebanadas hasta cubos, granulados a rallados, pastas a purés. Urschel fabrica más de 50 modelos de maquinaria de corte industrial.
VICTORY PRODUCTOS DE LIMPIEZA PROFESIONAL Marco Polo 4747 (1678) Caseros – Bs.As. – Argentina Tel: (54 11) 4759-9997 victory@victorylimpieza.com.ar www.victorylimpieza.com.ar Líderes en el desarrollo e implementación de programas y procesos de limpieza y desinfección. Porfolio amplio de elementos de limpieza profesional y sanitarios, incluyendo procesos que involucren altas temperaturas. Contamos con tecnología para formulaciones y equipos de aplicación con sistemas de dilución automática.
Av. Roque Sáenz Peña 729 (S2300) Rafaela – Santa Fe – Arg. Tel.: (54 3492) 432277/87 ventas@vmc.com.ar; www.vmc.com.ar
Producción, instalación y puesta en marcha de sistemas de frío industrial.
CASA CENTRAL: Ruta 11 Km 1006,5 Resistencia Chaco. Tel.: (0362) 446 1500
CÓRDOBA: Duarte Quirós 3642 Tel.: (0351) 4808190
MENDOZA: El Algarrobo 1039 B° Brisas del Parque - Maipú Cel.: (0261) 6243742
ROSARIO: San Lorenzo 4712 Tel.: (0341) 4398250 | 4389600
PUERTO MADRYN: Neuquén 888 Cel.: 02284 56-7962 info@warbel.com.ar www.warbel.com.ar
Cintas transportadoras para la industria alimentaria, Servicio técnico, mantenimiento, comercialización de accesorios,

